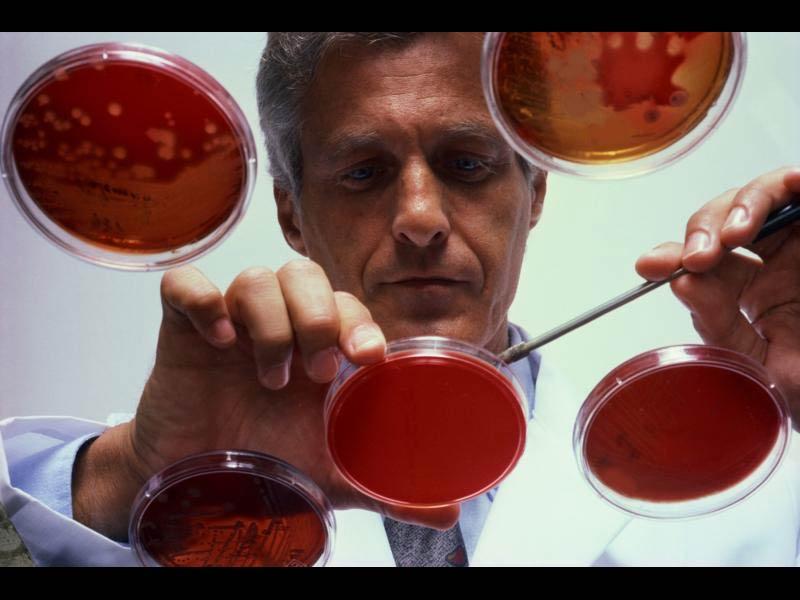
Evrimi Kabul Eden Bilim Adamlarının Listesi

|
|
|
|
Güncelleme: Listeye Yeni Katılan 100 Bilim İnsanın Listesi
|
|
|
|
İkinci Güncelleme: Eklenen 100 Bilim Adamı Daha
|
|
|
|
Listenin Devamı: En Son Güncelleme Tarihi: 3 Mayıs 2012
Steven M. Kolodziejczyk***
Biologist, Biotechnology, Canadian Intellectual Property Office
Ph.D., Molecular Biology, Dalhousie University
Steven E. Koonin
Provost and Professor of Theoretical Physics, California Institute of Technology
Ph.D., Theoretical Physics, Massachusetts Institute of Technology
Steve Korenstein*******
Physician, Mercy Health Systems
M.S., Public Health, California State University, Northridge; M.D., Ross University School of Medicine
Lead author, “An exposure assessment of PM10 from a major highway interchange: Are children in nearby schools at risk?” Journal of Environmental Health 2002, 65(2):9-17, 37
F. Steven Korte******
Senior Fellow, Department of Bioengineering, University of Washington
Ph.D., Physiology, University of Missouri
Steven T. Kosak******
Assistant Professor, Department of Cell and Molecular Biology, Feinberg School of Medicine, Northwestern University
Ph.D., Molecular Genetics and Cell Biology, University of Chicago
Steven E. Kotsonis******
Technical Manager, Bioapplications, Orica Mining Services
Ph.D., Biochemistry and Molecular Biology, University of Melbourne
Stephen Kowalczykowski
Professor of Microbiology and of Molecular & Cell Biology, University of California, Davis
Ph.D., Chemistry (Biochemistry), Georgetown University
Stephen A. Kowalewski*
Professor of Anthropology, University of Georgia
Ph.D., Anthropology, University of Arizona
Stephen W. Kress******
Vice President for Bird Conservation and Director of the Seabird Restoration Program of the National Audubon Society
Ph.D., Environmental Education, Cornell University
Helped to restore nesting Atlantic puffin colonies to the Maine coast
Steve Kristoff****
Assistant Professor of Science, Ivy Tech Community College
Ph.D., Medical Biophysics, Indiana University
Stephen J. Kron**
Professor of Molecular Genetics and Cell Biology, University of Chicago
Ph.D., Cell Biology, and M.D., Stanford University
Steve Krone******
Professor of Mathematics, University of Idaho
Ph.D., Mathematics, University of Massachusetts
Steven L. Kuhn
Associate Professor of Anthropology, University of Arizona
Ph.D., Anthropology, University of New Mexico
Stephen E. Kurtz*******
Instructor of Biology, Portland Community College
Ph.D., Molecular Genetics and Cell Biology, University of Chicago
First author, “An ancient developmental induction: Heat shock proteins induced in sporulation and oogenesis,” Science (1986) 231:1154-1157.
Stephen G. LaBonne
DNA Analyst, Lake County, Ohio, Crime Laboratory
Ph.D., Biochemistry and Molecular Biology, Northwestern University
Fellow (Molecular Biology) of the American Board of Criminalistics
Steve Labrie*******
Assistant Professor, Department of Food Sciences and Nutrition, Université Laval
Ph.D., Microbiology, Université Laval
Steve Lack*******
Associate Professor of Mathematics, Macquarie University
Ph.D., Mathematics, Cambridge University
Recipient, Australian Mathematical Society Medal, 2009
Steven A. Lack*******
Research Associate, Cooperative Institute for Research in Environmental Sciences, University of Colorado, Boulder and NOAA/Earth System Research Laboratory
Ph.D., Soil and Atmospheric Science, University of Missouri, Columbia
Steve La Grow***
Professor of Rehabilitation and Head, School of Health Sciences, Massey University
Ed.D., Teacher Education/Special Education, Northern Illinois University
Stephen A. Lammert******
Director, Mass Spectometry Development, Stillwater Scientific Instruments
Ph.D., Analytical Chemistry, Purdue University
Steven A. Langer***
President, Abbott, Langer, & Associates, Inc.
Ph.D., Psychology, Walden University
Past President, Chicago Psychological Society
Steven M. Lanoux******
Assistant Director for Operations, University of Texas Marine Science Institute
Ph.D., Human Systems Management, Pacific Western University
Program manager for a multi-university research project in the Chukchi Sea, funded by Minerals Management Service, prior to oil and gas exploration in that region, and the largest research award for the Marine Science Institute
Steve Lansing***
Research Professor, Santa Fe Institute
Professor, Departments of Anthropology and Ecology & Evolutionary Biology, University of Arizona
Ph.D., Anthropology, University of Michigan
Stephen Laurence*
Director, Innateness and Structure of the Mind Project, University of Sheffield
Ph.D., Philosophy, Rutgers University
Stephen S. Lawrence******
Associate Professor of Physics and Astronomy, Hofstra University
Ph.D., Astronomy, University of Michigan
Stephen E. G. Lea
Deputy Vice-Chancellor, University of Exeter
Ph.D., Psychology, Cambridge University
Accredited lay preacher of the Methodist Church
Steven C. Le Comber******
Lecturer in Anatomy, School of Biological and Chemical Sciences, Queen Mary, University of London
Ph.D., Biology, University of London
Steven Bruce Legg
Software Architect, Adacel Technologies Ltd
Ph.D., Computer Science, Monash University
Steven L. Lehman
Professor of Integrative Biology, University of California, Berkeley
Ph.D., Biophysics, University of California, Berkeley
Stephen James Leigh***
Group Safety, Health, and Environment Adviser, Croda International PLC
Ph.D., Organic Chemistry, University of Sheffield
Stephen H. Lekson*
Associate Professor of Anthropology and Curator of Anthropology, Museum of Natural History, University of Colorado
Ph.D., Anthropology, University of New Mexico
Steven R. Lentz*****
Professor of Internal Medicine, University of Iowa
Ph.D., Molecular Biology, Washington University
Stephen H. Lepp***
Professor of Physics, University of Nevada, Las Vegas
Ph.D., Physics, University of Colorado
Stephen Leslie******
Post-Doctoral Researcher, Mathematical Genetics Group, Department of Statistics, Oxford University
D.Phil., Statistics, Oxford University
Stephen A. Leslie*
Associate Professor of Geology, University of Arkansas, Little Rock
Ph.D., Geology, Ohio State University
Stefan Leuko*******
NPP Fellow, Oak Ridge Associate Universities
Ph.D., Astrobiology, Australian Centre for Astrobiology
Stephan Lewandowsky*******
Australian Professorial Fellow, School of Psychology, University of Western Australia
Ph.D., Psychology, University of Toronto
Stephen D. Levene*
Associate Professor of Molecular and Cell Biology, University of Texas, Dallas
Ph.D., Chemistry, Yale University
Stephanie Levi******
Coordinator, Student Center for Science Engagement, Northeastern Illinois University
Ph.D., Molecular Genetics and Cell Biology, University of Chicago
Author, “The Yeast GRASP Homologue Grh1 Localizes to tER Sites and is Dispensible for the Organization of the Secretory Pathway in the Budding Yeasts Saccharomyces and Pichia pastoris” (submitted)
Stephen D. Lewis*******
Associate Professor and Chair, Department of Earth and Environmental Sciences, California State University, Fresno
Ph.D., Geological Sciences, Columbia University, Lamont-Doherty Earth Observatory
Steven P. Lewis*
Associate Professor of Physics, University of Georgia
Ph.D., Physics, University of California, Berkeley
Steven W. L’Hernault*****
Professor of Biology, Emory University
Ph.D., Biology, Yale University
Stephen J. Libby*****
Research Associate Professor of Laboratory Medicine, University of Washington School of Medicine
Ph.D., Zoology, Iowa State University
Coauthor, “Co-regulation of Salmonella enterica genes required for virulence and resistance to antimicrobial peptides by SlyA and PhoP/PhoQ,” Molecular Microbiology, 2005 Apr; 56 (2): 492-508.
Stephen Liberles******
Assistant Professor of Cell Biology, Harvard Medical School
Ph.D., Chemistry, Harvard University
Member of team that discovered novel olfactory receptors and can monitor how they evolved in the genomes of diverse vertebrates — from fish to mice to humans
Steven M. Lidia*****
Staff Scientist, Lawrence Berkeley National Laboratory
Ph.D., Physics, University of California, Davis
Stefan Liess******
Research Scientist, Stony Brook University
Ph.D., Meteorology, Max-Planck-Institute
Steven L. Lima
Professor of Life Sciences, Indiana State University
Ph.D., Population Biology, University of Rochester
Stephen Ling****
Consultant, The World Bank
Ph.D., Conservation Biology, Imperial College, London
Steven Paul Linke******
Senior Scientist, Prediction Sciences
Ph.D., Biology, University of California, San Diego
Stefan G. Llewellyn Smith**
Assistant Professor of Environmental Engineering, University of California, San Diego
Ph.D., Applied Mathematics, Cambridge University
Steve Lloyd***
Professor of Experimental Particle Physics, Queen Mary, University of London
Ph.D., Physics, Imperial College, London
Steven A. Lloyd****
Assistant Professor, Department of Psychology, Rhodes College
Ph.D., Anatomy and Neurobiology, University of Tennessee Health Science Center
Steven Lockton******
Post-Doctoral Scholar, Department of Biology, University of California, San Diego
Ph.D., Biological Sciences, University of California, Irvine
J. Stephen Lodmell**
Associate Professor of Biochemistry, University of Montana, Missoula
Ph.D., Biology, Brown University
Steven T. LoDuca
Associate Professor of Geology, Eastern Michigan University
Ph.D., Geology, University of Rochester
Stefano Lonardi*****
Assistant Professor, Department of Computer Science and Engineering, University of California, Riverside
Ph.D., Computer Sciences, Purdue University
Stephen Londe****
Instructor, Life Sciences Department, Santa Monica College
M.D., Washington University School of Medicine
Fellow, American College of Surgeons and American College of Cardiology
Stephen P. Long******
Professor of Crop Sciences, Robert Emerson Professor, and Resident Scientist for the National Center for Supercomputing Applications, University of Illinois, Urbana-Champaign
Ph.D., Plant Sciences, University of Leeds
Fellow, American Association for the Advancement of Science
Stephen H. Loomis
Jean C. Tempel ’65 Professor of Zoology, Connecticut College
Ph.D., Zoology, University of California, Davis
Stephanie Loranger*******
Associate Director, Autism Consortium
Ph.D., Molecular Cell Biology, Washington University in St. Louis
Steven K. Lorch*****
Director (retired), Northville Laboratory, Forensic Science Division, Michigan State Police
Ph.D., Botany (Plant Physiology), University of Maryland
Steven J. Loring****
Assistant Director, Agricultural Experiment Station, New Mexico State University
Ph.D., Zoology, Michigan State University
Stephen C. Lougheed****
Assistant Professor of Biology, Queen’s University
Ph.D., Zoology, University of Western Ontario
Steven P. Love*******
Physicist, Los Alamos National Laboratory
Ph.D., Physics, Cornell University
Stefan Loverix******
Senior Scientist, Algonomics NV
Ph.D., Applied Biological Sciences, Vrije Universiteit Brussel
Steven Lowe******
Post-Doctoral Research Associate, South African Institute for Aquatic Biodiversity
Ph.D., Molecular Endocrinology, University of London
Steven Lowette******
Postdoctoral Researcher, Department of Physics, University of California, Santa Barbara
Ph.D., Physics, Vrije Universiteit Brussel
Stephen Luby*****
Head, Programme on Infectious Diseases and Vaccine Sciences, International Centre for Diarrhoeal Disease Research, Bangladesh, Centre for Health and Population Research
M.D., University of Texas, Southwestern Medical School
Coauthor, “Effect of handwashing on child health: a randomised controlled trial,” Lancet July 15, 2005; 366: 225-233.
Stephen Lucas******
Associate Professor of Mathematics, James Madison University
Ph.D., Mechanical Engineering, University of Sydney
Stephen C. Luce*
Licensed Psychologist (Pennsylvania, Massachusetts)
Ph.D., Developmental and Child Psychology, University of Kansas
Steven J. Luck
Professor of Psychology, University of Iowa
Ph.D., Neuroscience, University of California, San Diego
Winner of the Troland Award from the National Academy of Sciences, the Distinguished Scientific Award for Early Career Contribution to Psychology in the area of Behavioral and Cognitive Neuroscience from the American Psychological Association, and the F.J. McGuigan Young Investigator Prize from the American Psychological Foundation.
Steven Lundblad******
Assistant Professor of Geology, University of Hawai’i, Hilo
Ph.D., Geological Sciences, University of North Carolina, Chapel Hill
Stephen Andrew Lunn*
Research Fellow, Centre for Curriculum and Teaching Studies, Faculty of Education and Language Studies, The Open University
Ph.D., Science Education in Elementary Schools, The Open University
Stefan Luschnig
Postdoctoral Fellow?, Department of Biochemistry, Stanford University
Ph.D., Genetics, University of Tuebingen
Steven Raymond Lustig*
Senior Scientist, Dupont Central Research and Development
Adjunct Professor of Chemical Engineering, University of Delaware
Ph.D., Chemical Engineering, Purdue University
Steven P. Lynch
Professor of Biological Sciences, Louisiana State University, Shreveport
Ph.D., Plant Systematics and Ecology, University of California, Davis
Stefan Maas******
Assistant Professor, Department of Biological Sciences, Lehigh University
Ph.D., Molecular and Cellular Neurobiology, University of Heidelberg
Stephen A. Maas***
Chief Scientist, Applied Wave Research
Ph.D., Electrical Engineering, University of California, Los Angeles
Fellow, Institute of Electrical and Electronic Engineers
Stephen P. Mackessy
Professor of Biological Sciences, University of Northern Colorado
Ph.D., ?, Washington State University
Stephen L. Macknik******
Director, Laboratory of Behavioral Neurophysiology, Barrow Neurological Institute
Ph.D., Neurobiology, Harvard University
Co-author, “Windows on the Mind,” cover article in Scientific American, August 2007
Stephen Maddock*
Lecturer in Computer Science, University of Sheffield
Ph.D., 3D Computer Graphics, University of Sheffield
Stephanie Lee Madson*
Post-Doctoral Research Associate, Warnell School of Forest Resources, University of Georgia
Ph.D., Ecology, Institute of Ecology at the University of Georgia
Stephen Main*
Professor of Biology, Wartburg University
Ph.D., Biology, Oregon State University
Stephanie A. Majewski******
Postdoctoral Research Associate, Brookhaven National Laboratory
Ph.D., Applied Physics, Stanford University
Stephen B. Malcolm
Associate Professor of Biological Sciences, Western Michigan University
Ph.D., Zoology/Entomology, University of Oxford
Steven M. Malinak***
Assistant Professor of Chemistry, Washington & Jefferson College
Ph.D., Chemistry, University of Michigan
Stephen A. Mang******
Lecturer, Department of Chemistry & Biochemistry, University of Maryland, Baltimore County
Ph.D., Chemistry, University of California, Irvine
Steven L. Manly***
Associate Professor and Mercer Brugler Distinguished Teaching Professor, Department of Physics and Astronomy, University of Rochester
Ph.D., Physics, Columbia University
Carnegie Foundation 2003 New York State Professor of the Year
Stevan Marcus*******
Associate Professor of Biological Sciences, University of Alabama
Ph.D., Program in Cellular, Molecular, and Developmental Biology, University of Tennessee
Steven J. Marcus******
Science editor/writer, self-employed
Ph.D., Engineering, Harvard University
Former editor-in-chief, MIT’s Technology Review
Stephen M. Marek*
Assistant Professor of Entomology and Plant Pathology, Oklahoma State University
Ph.D., Plant Pathology, University of California, Davis
Stephen Maren*****
Associate Professor, Department of Psychology and Neuroscience Program, University of Michigan
Ph.D., Biological Sciences (Neurobiology), University of Southern California
Recipient of the APA Distinguished Scientific Award for an Early Career Contribution to Psychology
Steven J. Margheim******
Gemini Science Fellow, Gemini Observatory
Ph.D., Astronomy, Indiana University
Stefano Mariani******
Lecturer in Fish Population Biology, School of Biology and Environmental Science, University College Dublin
Ph.D., Animal Biology, University of Rome “La Sapienza”
Author, “Can spatial distribution of ichthyofauna describe marine influence on coastal lagoons? A Central Mediterranean case study,” Estuarine Coastal Shelf Science 2001; 52: 261-267
Stephanie Marin**
Research and Development Scientist, Institute for Clinical and Experimental Pathology, ARUP Laboratories
Ph.D., Chemistry, Arizona State University
Stephen J. Marks*****
Professor of Clinical Neurology, New York Medical College
M.D., New York Medical College
Coauthor, “Apneic Oxygenation in Apnea Tests for Brain Death: A Controlled Trial,” Archives of Neurology (1990) 47 (10): 1066-1068.
Steven J. Marqusee***
Associate Dean, Arts and Sciences and Professor of Anthropology, State University of New York, Potsdam
Ph.D., Anthropology, State University of New York, Albany
J. Stephen Marron******
Amos Hawley Distinguished Professor of Statistics and Operations Research, University of North Carolina, Chapel Hill
Ph.D., Mathematics, University of California, Los Angeles
Stephen J. Marshall***
Senior Lecturer, University Teaching Development Centre, Victoria University of Wellington
Ph.D., Biochemistry, Victoria University of Wellington
Stephen Marsland****
Lecturer in Information Sciences, Massey University
Ph.D., Mathematics and Computer Science, University of Manchester
G. Steven Martin***
Richard and Rhoda Goldman Professor of Cell and Developmental Biology, University of California, Berkeley
Ph.D., Molecular Biology, Cambridge University
Fellow, Royal Society
Steven Marygold******
Senior Research Associate, Department of Genetics, Cambridge University
Ph.D., Genetics, University College London
Steven J. Massey****
Senior Research Scientist, Eagle Aeronautics, Inc.
Ph.D., Aerospace Engineering, Old Dominion University
Stephen Matheson******
Associate Professor of Biology, Calvin College
Ph.D., Neuroscience, University of Arizona
Steven Mathews*
Associate Professor of Ophthalmology and Visual Sciences and Director of the Contact Lens and Low Vision Clinics, Texas Tech University Health Science Center
Ph.D., Physiological Optics, State University of New York College of Optometry
Stephen L. Mathias******
Senior Research Scientist, Division of Biocomputing, University of New Mexico School of Medicine
Ph.D., Human Genetics, Johns Hopkins University
Steven W. Matson****
Professor and Chairman, Department of Biology, University of North Carolina, Chapel Hill
Ph.D., Biochemistry, University of Rochester
Stephen F. Matter*****
Curator of Zoology and Field Ecologist, Cincinnati Museum Center
Ph.D., Environmental Sciences, University of Virginia
Steven A. Matthews*****
Professor of Economics, University of Pennsylvania
Ph.D., Economics, California Institute of Technology
Coauthor, “Dynamic Voluntary Contribution to a Public Project,” Review of Economic Studies (2000) 67 (231): 327-358.
Stephan Matthiesen*
Postdoctoral Research Assistant, Institute for Meteorology, Edinburgh University
Ph.D., Oceanography, Edinburgh University
Editor, Skeptiker
Steven L. Matzner*
Associate Professor of Biology, Augustana College
Ph.D., Plant Ecology, University of California, Davis
Steven S. Maughan*
Professor of History, The College of Idaho
Ph.D., History, Harvard University
Stefan Maus*******
Software Engineer, University of Freiburg
Ph.D. (Dr. ing.), Computer Science, University of Freiburg
Stephen J. Maxfield*
Senior Research Fellow, Department of Physics, University of Liverpool
Ph.D., Physics, University of Maryland
Stephanie Mayer*
Senior Instructor in Ecology and Evolutionary Biology, University of Colorado, Boulder
Ph.D., Botany, University of California, Berkeley
Esteban O. Mazzoni******
Postdoctoral Fellow, Pathology Department, Columbia University
Ph.D., Development and Neurobiology, New York University
Stephen McAdam******
Professor of Mathematics, University of Texas at Austin
Ph.D., Mathematics, University of Chicago
Steven J. McBryant*****
Director of the Keck Biomolecular Ultracentrifugation Facility, Department of Biochemistry and Molecular Biology, Colorado State University
Ph.D., Biochemistry and Biophysics, Colorado State University
Stephen McCauley******
Chief Investment Officer, Winton Capital Management Limited
D.Phil, Bioinformatics, Oxford University
Steven A. McCollum******
Associate Professor of Biology, Cornell College
Ph.D., Zoology, Duke University
Author, “Costs and benefits of a predator-induced polyphenism in the gray treefrog Hyla chrysoscelis,” Evolution (1996) 50: 583-593.
Stephan R. McCandliss******
Principal Research Scientist, Department of Physics and Astronomy, Johns Hopkins University
Ph.D., Astrophysics, University of Colorado, Boulder
Steven McCommas*
Professor and Chair of Biological Sciences, Southern Illinois University Edwardsville
Ph.D., Biology, University of Houston
Steven P. McConnell*
Silviculturist, Northwest Indian Fisheries Commission
Ph.D., Forestry, Range, and Wildlife Sciences, University of Idaho
Steve McCormick*****
Professor of Applied Mathematics, University of Colorado, Boulder
Ph.D., Mathematics, University of Southern California
Steven McCullagh
Professor of Biology, Kennesaw State University
D.A., Biology, Idaho State University
Stefan I. McDonough*****
Senior Scientist, Department of Neuroscience, Amgen, Inc.
Ph.D., Biology, California Institute of Technology
Member of Adult Choir, Christ Church Cambridge
Stephen M. McDuffie*
Scientist, United States Department of Energy
Ph.D., Earth and Planetary Sciences, Johns Hopkins University
Stephen T. McGarvey
Professor of Community Health & Director, International Health Institute, Brown University
Ph.D., Anthropology, Pennsylvania State University
Stephen P. McIninch*****
Research Assistant Professor, Center for Environmental Studies, Virginia Commonwealth University
Ph.D., Marine-Estuarine-Environmental Science, University of Maryland
Stephen W. McKechnie*****
Associate Professor of Genetics, Monash University
Ph.D., Ecological Genetics, University of Sydney
Steven L. McKnight******
Professor and Chair, Department of Biochemistry, University of Texas Southwestern Medical Center
Ph.D., Biology, University of Virginia
Member of the National Academy of Sciences
W. Stephen McNeil******
Assistant Professor of Chemistry, University of British Columbia, Okanagan
Ph.D., Chemistry, University of British Columbia
Stephen G. Mech******
Assistant Professor of Biology, Albright College
Ph.D., Zoology, Washington State University
Steph B. J. Menken******
Professor of Evolutionary Biology, University of Amsterdam
Ph.D., Evolutionary Systematics, University of Leiden
Member of The Royal Netherlands Academy of Arts and Sciences
Stefano Mersi******
Fellow, CERN
Ph.D., Physics, Università degli Studi di Firenze
Steve Meshnick*******
Professor of Epidemiology, Microbiology, and Immunology, University of North Carolina, Chapel Hill
M.D., Cornell University; Ph.D., Medical Biochemistry, Rockefeller University
Stephanie K. Mewborn****
Post-Doctoral Scholar, Department of Medicine, University of Chicago
Ph.D., Genetics, University of Chicago
Stephen C. Meyers*******
Taxonomic Director, Oregon Flora Project
Ph.D., Botany, Oregon State University
M. Stephen Meyn****
Professor of Molecular and Medical Genetics, University of Toronto
M.D., Ph.D., Pathology, New York University
Stephen Michnick******
Professor and Canada Research Chair in Integrative Genomics, Département de Biochimie, Université de Montreal
Ph.D., Biochemistry, University of Toronto
Steve Mifflin******
Professor and Chair, Deptartment of Integrative Physiology, University of North Texas Health Science Center
Ph.D., Physiology and Biophysics, University of Texas Medical Branch
Stephen A. Miller
Professor of Biology, College of the Ozarks
Ph.D., Zoology, University of Wisconsin, Madison
Coauthor, Zoology
Stephen M. Miller
Assistant Professor of Biology, University of Maryland, Baltimore County
Ph.D., Biology, Massachusetts Institute of Technology
Stephen T. Miller******
Assistant Professor, Department of Chemistry and Biochemistry, Swarthmore College
Ph.D., Biophysics, Harvard University
Steven L. Miller*******
Research Professor, Department of Biology and Marine Biology, University of North Carolina, Wilmington
Ph.D., Botany, University of Massachusetts, Amherst
Steven W. Miller******
Post-Doctoral Fellow, University of California, San Diego
Ph.D., Biology, University of California, San Diego
Steve Minchin******
Senior Lecturer, School of Biosciences, University of Birmingham
D.Phil., Biochemistry, University of Sussex
Stephen Mitchell******
Postdoctoral Associate in Ecology, Duke University
Ph.D., Forest Science, Oregon State University
Steve Mockford******
Assistant Professor, Biology Department, Acadia University
Ph.D., Biology, Dalhousie University
Stephen J. Mojzsis
Professor of Geochemistry, University of Colorado
Ph.D., Geochemistry, Scripps Institution of Oceanography, University of California, San Diego
Stephen Molloy******
Experimental physicist, Stanford Linear Accelerator Center
Ph.D., Accelerator Physics, Queen Mary College, University of London
Stephen Mondy*
Research Fellow, Macquarie Centre for Cognitive Science, Macquarie University
Ph.D., Psychology, Macquarie University
Stephen Monismith
Professor of Environmental Fluid Mechanics, Stanford University
Ph.D., Civil Engineering, University of California, Berkeley
National Science Foundation Presidential Young Investigator 1989
Stephen Montgomery******
Postdoctoral Researcher, Population and Comparative Genomics Group, Wellcome Trust Sanger Institute
Ph.D., Genetics, University of British Columbia
Stephen Montgomery*******
The Royal Commission for the Exhibition of 1851 Research Fellow, Department of Zoology, Oxford University
Ph.D., Evolutionary Biology, Cambridge University
Stephen J. Moorman****
Associate Professor of Neuroscience and Cell Biology, Robert Wood Johnson Medical School
Ph.D., Anatomy and Neurobiology, Colorado State University
Stephen P. Moose******
Associate Professor of Maize Genomics, University of Illinois, Urbana-Champaign
Ph.D., Genetics and Crop Science, North Carolina State University
Author, “Maize selection passes the century mark: A unique resource for 21st century genomics,” Trends in Plant Science (2004) 9: 358-364.
Stephen Moreton*****
Research Chemist, Ineos Silicas Ltd.
Ph.D., Chemistry, University of Edinburgh
Steven Wayne Morgan******
Postdoctoral Researcher, ENS-Paris and CEA-Saclay
Ph.D., Physics, University of Utah
Stephen G. Morris******
Assistant Professor of Philosophy, Missouri Western State University
Ph.D., Philosophy, Florida State University
Steve Morris*
Child Clinical Psychologist, Department of Child and Adolescent Psychiatry, Royal Free Hospital in Hampstead, London
D.Clin.Psy., University College, London
Steven L. Morris***
Professor of Physics, Los Angeles Harbor College
Ph.D., Physics, University of Calgary
Member, American Astronomical Society, Royal Astronomical Society of Canada
Steven J. Morrison***
Associate Professor of Music, University of Washington, Seattle
Ph.D., Music, Louisiana State University
Coauthor, “Exploring the influence of cultural familiarity and expertise on neurological responses to music,” Annals of the New York Academy of Sciences (2003); 999:112-117.
Stephen A. Morse*
Associate Director for Science, Bioterrorism Prepardness and Response Program, National Center for Infectious Diseases, Centers for Disease Control and Prevention; Adjunct Professor of Microbiology and Immunology, Emory University
Ph.D., Microbiology, University of North Carolina
Fellow of the American Academy of Microbiology; Senior Biomedical Research Service, United States Public Health Service
Stephen P. Morse******
Ph.D., Electrical Engineering, New York University
Stephen Mortlock***
Team Leader, Department of Immunology, Quest Diagnostics
D.Sc., Health Sciences, Marlborough University
Established a microbiology laboratory at the Imran Khan Cancer Hospital, Lahore, Pakistan
Steve Moulton*
Biological Operations Manager, National Water-Quality Assessment Program, United States Geological Survey
Ph.D., Biology, University of North Texas
Stephen M. Mount
Associate Professor of Cell Biology and Molecular Genetics, University of Maryland
Ph.D., Molecular Biology, Yale University
Steve Movit*******
Ph.D., Astronomy and Astrophysics, Pennsylvania State University
Stephen N. Mueller******
Director of Manufacturing, Wellstat Biologics Corporation
Ph.D., Biology, Syracuse University
Steven W. Mueller*****
Software developer, National Center for Atmospheric Research
Ph.D., Geophysics, Southern Methodist University
Esteban Muldavin*
Research Associate Professor in Biology, University of New Mexico
Ph.D., Biology, New Mexico State University
Stephen S. Mulkey
Associate Professor of Botany, University of Florida, Gainesville
Ph.D., Evolutionary Ecology, University of Pennsylvania
Stephen J. Mullin
Assistant Professor of Biological Sciences, Eastern Illinois University
Ph.D., Biology, University of Memphis
Stephen H. Munroe
Professor of Biological Sciences, Marquette University
Ph.D., Chemistry, Indiana University
Steven Murov**
Professor of Chemistry, Modesto Junior College
Ph.D., Organic Photochemistry, University of Chicago
Steve Murphree*******
Professor of Biology, Belmont University
Ph.D., Entomology, Auburn University
Stephen A. Murphy******
Ecologist, Australian Wildlife Conservancy
Ph.D., Zoology, Australian National University
Author, “The phylogeography of palm cockatoos, Probosciger aterrimus, in the dynamic Australo-Papuan region,” Journal of Biogeography 2007: 34, 1534-1545
Stephen D. Murphy*****
Associate Professor, Environment and Resource Studies, University of Waterloo
Ph.D., Biology, Queen’s University
Chair, Society for Ecological Restoration Ontario; Co-Chair, Parks Research Forum of Ontario; Co-Director of Research, Rare Research Reserve
Steven Myers****
Assistant Professor, School of Informatics, Indiana University
Ph.D., Computer Science, University of Toronto
Steven F. Myers
Associate Professor of Biology, University of Michigan, Flint
Ph.D., Anatomy and Cell Biology, University of Michigan
Member of the Association for Research in Otolaryngology
Steven T. Myers*
Staff Scientist, National Radio Astronomy Observatory
Ph.D., Astronomy, California Institute of Technology
Stephen G. Naculich*****
Professor of Physics, Bowdoin College
Ph.D., Physics, Princeton University
Steven A. Nadler
Professor of Nematology, University of California, Davis
Ph.D., Medical Parasitology, Lousiana State University Medical Center
Stephen A. Naftilan*****
K. Pitzer Chair of Physics, Joint Science Department, The Claremont Colleges
Ph.D., Astronomy, Case Western Reserve University
Stephen E. Nagler*******
Corporate Research Fellow, Oak Ridge National Laboratory
Ph.D., Physics, University of Toronto
Steve Nahn*
Research Associate, Yale University
Ph.D., Physics, Massachusetts Institute of Technology
Stephan P. Nelson******
Program Director, Physical and Dynamic Meteorology, National Science Foundation
Ph.D., Meteorology, University of Oklahoma
Stephen O. Nelson****
Professor of Physics, University of Texas, Permian Basin
Ph.D., Physics, Duke University
Steven L. Neuberg
Professor of Psychology, Arizona State University
Ph.D., Social Psychology, Carnegie Mellon University
Coauthor, Social Psychology: Unraveling the Mystery
Stephan Neuhauss******
Associate Professor of Neurobiology, University of Zurich
Ph.D., Developmental Genetics, University of Tübingen
Stefan Nilsson******
Professor of Computer Science, Royal Institute of Technology, Stockholm
Ph.D., Computer Science, Lund University
Stephen C. Noctor*******
Assistant Professor of Psychiatry and Behavioral Sciences, University of California, Davis
Ph.D., Neuroscience, Uniformed Services University
Coauthor, “Neurons derived from radial glial cells establish radial units in neocortex,” Nature (2001), 409: 714-720
Stephen C. Nodvin*****
Head, Department of Applied Mathematics and Sciences, Wentworth Institute of Technology
Ph.D., Ecology and Evolutionary Biology, Cornell University
Stephen C. Nold*****
Associate Professor of Biology, University of Wisconsin, Stout
Ph.D., Microbiology, Montana State University
Steven K. Nordeen******
Professor & Director, Cancer Biology Graduate Program, and Co-director, Prostate Cancer Research Laboratories, University of Colorado, Denver
Ph.D., Biophysics, University of Rochester
Stephen Norley
Head, AIDS Pathogenesis and Vaccine Development, Robert Koch-Institut
Ph.D., Biology, Animal Virus Research Institute / Institutes for Animal Health
Steven P. Norman******
Adjunct Professor, Geography Department, Humboldt State University, and Research Ecologist, USDA Forest Service
Ph.D., Geography, Pennsylvania State University
Stephen Nottingham***
Science writer
Ph.D., Applied Biology, Cambridge University
Steven P. Novella
Assistant Professor of Neurology, Yale University School of Medicine
M.D., Georgetown University
President of the New England Skeptical Society
Stephen Nowicki
Anne T. & Robert M. Bass Professor of Biology, Neurobiology, and Psychological and Brain Sciences, Duke University
Ph.D., Neurobiology and Behavior, Cornell University
Fellow, John Simon Guggenheim Foundation (1999)
Steven Nutt*****
M. C. Gill Professor and Senior Associate Dean for Research, Viterbi School of Engineering, University of Southern California
Ph.D., Materials Science, University of Virginia
Steven Obrebski****
Senior Research Scientist/Lecturer, Romberg Tiburon Center for Environmental Studies, San Francisco State University
Ph.D., Paleozoology, University of Chicago
Member, Society for the Study of Evolution
Stephen J. O’Brien
Chief, Laboratory of Genomic Diversity, National Cancer Institute
Ph.D., Genetics, Cornell University
Author, Tears of the Cheetah
Steve L. O’Kane, Jr.*
Professor of Biology, University of Northern Iowa
Ph.D., Evolutionary and Population Biology, Washington University in St. Louis
Stephen Okkonen******
Research Associate Professor of Marine Science, Institute of Marine Science, University of Alaska, Fairbanks
Ph.D., Physical Oceanography, University of Alaska, Fairbanks
Steve Oliver******
Hybrid Integration Scientist, Centre for Integrated Photonics
Ph.D., Organic Chemistry, University College of Wales
Fellow of the Royal Society of Chemistry
Steve Olson*******
Chief Executive Officer, SightLine Applications
Ph.D., Cognitive and Neural Systems, Boston University
Steven Wayne O’Neal**
Associate Professor of Biology, Southwestern Oklahoma State University
Ph.D., Biology, University of Miami
Stephen O’Rahilly******
Professor of Clinical Biochemistry and Medicine and Director, Metabolic Research Laboratories, University of Cambridge
M.D., National University of Ireland
FRCP, FRCPI, FRCPath, FRS, FMed Sci
Steven Orzack
President and Senior Research Scientist, Fresh Pond Research Institute
Ph.D., Biology, Harvard University
Coeditor, Adaptationism and Optimality
Stephen James Osborne***
Marketing and Business Development Director, Autotype International
Ph.D., Organometallic Chemistry, University of Leeds
Steve O’Shea***
Senior Research Fellow and Discovery Channel Quest Scholar, Earth & Oceanic Sciences Research Institute, Auckland University of Technology
Ph.D., Biology?, University of Auckland
Steven J. Ostro***** †
Senior Research Scientist, Jet Propulsion Laboratory
Ph.D., Planetary Sciences, Massachusetts Institute of Technology
Stephen Ousley
Director, Osteology Laboratory, Smithsonian Institution
Ph.D., Biological Anthropology, University of Tennessee, Knoxville
Stephen R. Overmann*******
Director, Environmental Science Program, Southeast Missouri State University
Ph.D., Experimental Psychology, Michigan State University
Steve Paddock
Researcher, Laboratory of Molecular Biology, University of Wisconsin, Madison
Ph.D., Physiology and Cell Biology, University of Bristol
Editor, Confocal Microscopy: Methods & Protocols
Steven D. Pain*******
Experimental Nuclear Astrophysicist, Physics Division, Oak Ridge National Laboratory
Ph.D., Experimental Nuclear Physics, University of Surrey
Stephen R. Palumbi
Professor of Marine Sciences, Stanford University
Ph.D., Marine Ecology, University of Washington
Author, The Evolution Explosion
Stephanie A. Pangas******
Assistant Professor, Department of Pathology, Baylor College of Medicine
Ph.D., Neurobiology and Physiology, Northwestern University
Stephen Park*
Postdoctoral Research Fellow, Department of Clinical Pharmacology, Royal College of Surgeons in Ireland
Ph.D., Genetics, Trinity College, Dublin
Stephen Parke*******
Senior Scientist, Theoretical Physics Department, FermiLab
Ph.D., Theoretical Physics, Harvard University
Co-discoverer of the maximal helicity violating amplitudes in QCD; coauthored “An Amplitude for n-Gluon Scattering,” Physical Review Letters(1986) 56:2459-2460.
Stephen C. Parker****
Visiting Assistant Professor, Department of Physics and Astronomy, Carleton College
Ph.D., Physics, University of Washington
Stephen C. J. Parker******
Postdoctoral Fellow, Genome Technology Branch, National Human Genome Research Institute, National Institutes of Health
Ph.D., Bioinformatics, Boston University
Steven Parker****** †
Associate Professor of Pediatrics, Boston University School of Medicine
M.D., University of Michigan Medical School
Co-author, Dr. Spock’s Baby and Child Care, 7th edition
Stephen M. Pasquale*
Staff Biologist and Curriculum Developer, Biological Sciences Curriculum Study
Ph.D., Cellular and Integrative Biology, Washington University in St. Louis
Stephen Pate****
Associate Professor of Physics, New Mexico State University
Ph.D., Physics, University of Pennsylvania
Steve Paterson******
Lecturer, School of Biological Sciences, University of Liverpool
Ph.D., Genetics, Cambridge University
Steve Patitsas*****
Assistant Professor of Physics, University of Lethbridge
Ph.D., Physics, University of British Columbia
Stephen Pearce******
Postdoctoral researcher, Department of Plant Sciences, University of California, Davis
Ph.D., Plant Molecular Biology, University of Bristol
Stephen C. Peck******
Research Investigator, Institute for Social Research, University of Michigan
Ph.D., Personality Psychology, University of Michigan
Author, “TEMPEST in a gallimaufry: Applying multilevel systems theory to person-in-context research,” Journal of Personality 75:1127-1156.
Steven L. Peck*
Assistant Professor of Integrative Biology, Brigham Young University
Ph.D., Biomathematics, North Carolina State University
Steve Pells*
Research Fellow, Roslin Institute
Ph.D., Molecular Biology, Edinburgh University
Steven C. Pennings******
Associate Professor of Biology and Biochemistry, University of Houston
Ph.D., Biology, University of California, Santa Barbara
Stephen J. Peroutka****
President and CEO, Synergia Pharma, Inc.
Ph.D., Pharmacology, and M.D., Johns Hopkins University
Stephen A. Perrill******
Professor of Biology, Department of Biology, Butler University
Ph.D., Zoology, North Carolina State University
Stephen Petersen****
Mellon Postdoctoral Fellow, Kalamazoo College
Ph.D., Philosophy, University of Michigan
Stephen D. Petersen******
Post-Doctoral Researcher, Fisheries and Oceans Canada, ArcticNet
Ph.D., Environmental and Life Sciences, Trent University
Steven H. Peterson****
Ph.D., Physical Chemistry, University of Michigan
Steve Pettifer******
Lecturer, School of Computer Science, University of Manchester
Ph.D., Computer Science, University of Manchester
Stephen Pew******
President, Health Advocacy Leadership and Learning Organization
Ph.D., Educational Psychology and Measurements, University of Nebraska, Lincoln
Coauthor, Don’t Go There Alone! A Guide to Hospitals for Patients and Their Advocates
Stephen Phillips***
Research Engineer, IT Innovation Centre
Ph.D., Chemistry, University of Southampton
Steven J. Phillips****
Professor Emeritus, Department of Anatomy and Cell Biology, Temple University School of Medicine
M.D., Hahnemann University School of Medicine
Steven J. Phillips******
Researcher, AT&T Labs-Research
Ph.D., Computer Science, Stanford University
Co-author, “Aligning Conservation Priorities Across Taxa in Madagascar with High-Resolution Planning Tools,” Science 2008; 320 (5873): 222-226.
Steven J. Phipps******
Research Fellow, Climate Change Research Centre, University of New South Wales
Ph.D., Climatology, University of Tasmania
Stephen Piazza*******
Associate Professor, Department of Kinesiology, Pennsylvania State University
Ph.D., Mechanical Engineering, Northwestern University
Stephen J. Pickard***
Mathematics Instructor, Balgowlah Boys Campus, Northern Beaches Secondary College
Ph.D., Electronics, University of Cardiff
Coauthor, “Algorithmic and Implementation Issues in Analog Low Power Learning Neural Network Chips,” Journal of VLSI Signal Processing 1993; 6 (1): 67.
Stephen J. Picken****
Professor of Polymer Materials, Department of Chemical Engineering, Delft University of Technology
Ph.D., Physics/Physical Chemistry, Utrecht University
Stephen M. Pickles****
Technical Director, UK National Grid Service, Manchester Computing, University of Manchester
Ph.D., Theoretical Physics, University of Edinburgh
Stephen W. Pierson*
Associate Professor of Physics, Worcester Polytechnic Institute
Ph.D., Physics, University of Minnesota
Senior Science Policy Fellow for the American Physical Society
Stephen H. Pilder****
Associate Professor of Anatomy and Cell Biology, Temple University School of Medicine
Ph.D., Molecular Biology, Princeton University
Coauthor, “The mouse t complex distorter/sterility candidate, Dnahc8, expresses a gamma-type axonemal dynein heavy chain isoform confined to the principal piece of the sperm tail,” Developmental Biology (2005); 285: 57-69.
Steven Pinker
Johnstone Professor of Psychology, Harvard University
Ph.D., Experimental Psychology, Harvard University
Author, How the Mind Works
Steven Piantadosi*******
Phase One Foundation Endowed Chair, Director, Samuel Oschin Comprehensive Cancer Institute, and Professor of Medicine, Cedars-Sinai Medical Center
Professor in Residence, Departments of Medicine and Biomathematics, David Geffen School of Medicine, University of California, Los Angeles
M.D., University of North Carolina; Ph.D., Bioinformatics, University of Alabama, Birmingham
Steven T. Piantadosi*******
Postdoctoral Researcher, Department of Brain and Cognitive Sciences, University of Rochester
Ph.D., Brain and Cognitive Sciences, Massachusetts Institute of Technology
Steven Pirie-Shepherd*
Group Leader, Covx/Pfizer
Ph.D., Biochemistry, Edinburgh University
Steven M. Platek
Assistant Professor of Psychology, Drexel University
Ph.D., Psychology, State University of New York, Albany
Coauthor, “Reaction toward children’s faces: Resemblance matters more for males than females,” Evolution and Human Behavior, 2002: 23 (3), 159-166.
Stephen M. Platt******
Chief Technology Officer, Alterion Inc.
Ph.D., Computer Science, University of Pennsylvania
Steven Samuel Plotkin
Assistant Professor of Physics and Astronomy, University of British Columbia
Ph.D., Physics, University of Illinois, Urbana Champaign
Canadian Research Chair in Theoretical Molecular Biophysics
Steven Poelhekke******
Researcher, De Nederlandsche Bank
Ph.D., Economics, European University Institute
Stephen Pollaine*
Physicist, Lawrence Livermore National Laboratory
Ph.D., Astrophysics, University of California, Berkeley
Steven E. Poltrock*
Technical Fellow, The Boeing Company
Ph.D., Psychology, University of Washington
Stephan Pomp******
Assistant Professor, Department of Neutron Research, Uppsala University
Ph.D., Physics, Uppsala University
Steven W. Popper***
Professor of Science and Technology Policy, RAND Graduate School
Ph.D., Economics, University of California, Berkeley
Stephen F. Porcella****
Facility Head, Genomics Core Facility, National Institute of Allergy and Infectious Diseases, National Institutes of Health
Ph.D., Microbiology, University of Montana
Coauthor, “Variable Tick Protein in Two Genomic Groups of the Relapsing Fever Spirochete Borrelia hermsii in Western North America,” Infection and Immunity 73:10 (October 2005): 6647-6658
Steven A. Porcelli****
Murray and Evelyne Weinstock Professor of Microbiology and Immunology, Albert Einstein College of Medicine
M.D., Yale University
Stephen Porder******
Assistant Professor of Ecology and Evolutionary Biology, Brown University
Ph.D., Biological Sciences, Stanford University
Steve M. Potter*
Professor of Biomedical Engineering, Georgia Institute of Technology and Emory University
Ph.D., Neurology, University of California, Irvine
Steven L. Powers*******
Assistant Professor of Biology, Roanoke College
Ph.D., Biology, University of Alabama
Stephen Prata******
Retired instructor of astronomy, physics, and computer science, College of Marin
Ph.D., Astronomy, University of California, Berkeley
Member, American Astronomical Society
Stephen J. Pratt******
Postdoctoral Fellow, Department of Cell Biology, University of Virginia
Ph.D., Developmental Biology, Washington University
Stephen John Pratt******
Director, Calamia Enterprises Pty. Ltd.
Ph.D., Chemistry, Australian National University
Steven J. Presley****
Postdoctoral Associate, Center for Environmental Sciences and Engineering, Department of Ecology and Evolutionary Biology, University of Connecticut
Ph.D., Biological Sciences, Texas Tech University
Steve Pressé*******
Postdoctoral Scholar in Biophysics at the School of Pharmacy, University of California, San Francisco
Ph.D., Physical Chemistry, Massachusetts Institute of Technology
Stephen C. Preston*****
Assistant Professor of Mathematics, University of Colorado, Boulder
Ph.D., Mathematics, State University of New York, Stony Brook
Steven J. Prior****
Research Fellow, Division of Gerontology, University of Maryland School of Medicine
Ph.D., Kinesiology, University of Maryland
Steven J. Projan*
Vice President and Global Head, Infectious Diseases, Novartis Pharmaceuticals, Inc.
Ph.D., Molecular Genetics, Columbia University
Stephen R. Proulx****
Assistant Professor of Ecology, Evolution and Organismal Biology, Iowa State University
Ph.D., Biology, University of Utah
Stephen James Prowse*
Manager, Strategy and Evaluation, Division of Livestock Industries, Commonwealth Scientific & Industrial Research Organisation
Ph.D., Immunology, Adelaide University
Stephen Pruett-Jones
Associate Professor of Ecology and Evolution, University of Chicago
Ph.D., Zoology, University of California, Berkeley
Recipient, Llewellyn John and Harriet Manchester Quantrell Award for excellence in undergraduate teaching, University of Chicago, 1995.
Steve Purcell*****
Engineer/Programmer, ATK Thiokol Ph.D., Chemical Engineering, University of Utah
Stephen Quake*
Associate Professor of Applied Physics, California Institute of Technology D.Phil., Theoretical Physics, Oxford University
Steven A. Rabinowitz****
Research Staff Member, Institute for Defense Analyses
Ph.D., Elementary Particle Physics, Columbia University
Stephen D. Rader*****
Assistant Professor of Chemistry, University of Northern British Columbia
Ph.D., Biophysics, University of California, San Francisco
Recipient of the Parke-Davis Award for best paper in Protein Science in 1997
Steven Radosevich
Professor of Forest Science, Oregon State University
Ph.D., Oregon State University
Author, Weed Ecology
Stefan Rahmstorf
Professor of Physics, Potsdam University
Ph.D., Physical Oceanography, Victoria University of Wellington, New Zealand
Recipient, James S. McDonnell Foundation Centennial Fellowship Award
Steven A. Ramm*****
Postdoctoral Research Associate, University of Liverpool
Ph.D., Evolutionary Biology, University of Liverpool
Stephen R. Rannels****
Associate Professor of Cellular and Molecular Physiology, Pennsylvania State University
Ph.D., Physiology, Pennsylvania State University College of Medicine
Stephen J. Ratcliff**
Professor of Physics, Middlebury College
Ph.D., Astrophysical Sciences, Princeton University
Steven J. Ray*****
Scientist, Laboratory for Spectrochemistry, Indiana University
Ph.D., Chemistry, Indiana University
Steve Read*******
Chief Scientist, Forestry Tasmania, and Honorary Associate Professor, School of Forest & Ecosystem Science, University of Melbourne
Ph.D., Plant Biochemistry, Cambridge University
Stéphan Reebs****
Professor of Biology, Université de Moncton
Ph.D., Zoology, University of Toronto
Steve Reid*
Associate Professor of Analytical Chemistry, University of Saskatchewan
Ph.D., Analytical Chemistry, University of Alberta
Stephen M. Reilly******
Professor of Biological Sciences, Ohio University
Ph.D., Zoology, Southern Illinois University
Director, Ohio Center for Ecology and Evolutionary Studies
Steve Renals*
Professor of Speech Technology, University of Edinburgh
Ph.D., Speech Technology, University of Edinburgh
Stephen A. Renshaw******
MRC Clinician Scientist Fellow, Senior Clinical Lecturer, and Honorary Consultant Physician, University of Sheffield
Ph.D., Inflammation Biology, University of Sheffield
Steve Reuland*****
Ph.D., Biochemistry and Molecular Biology, Medical University of South Carolina
Steven K. Reynolds, Jr.***
Assistant Professor, Department of Biology, and Director, Environmental Sciences Program, Lake Erie College
Ph.D., Biology, University of Alabama
Stephen A. Rice*******
Associate Professor, Department of Microbiology, University of Minnesota
Ph.D., Cellular, Viral, and Molecular Biology, University of Utah
Stephen M. Rich*
Assistant Professor of Biomedical Sciences, Tufts University School of Veterinary Medicine
Ph.D., Genetics, University of California, Irvine
Stephen M. Richard**
Research Geologist, Arizona Geological Survey
Ph.D., Geology, University of California, Santa Barbara
Stephen Richards
Assistant Professor in the Human Genome Sequencing Center, Baylor College of Medicine
Ph.D., Biochemistry and Cell Biology, Rice University
Stephen Giles Richardson*
Program Director, BacT/ALERT Systems, Clinical Microbiology GM&SD, bioMerieux, Inc.
Ph.D., Organic Chemistry, University of Iowa
Discoverer of transient electron-deficient heteroaryl radicals as efficient synthetic intermediates, e.g., to halopurine nuclosides
Stephen Richter****
Assistant Professor of Biological Sciences, Eastern Kentucky University
Ph.D., Zoology, University of Oklahoma
Stephen T. Ridgway***
Astronomer, National Optical Astronomy Observatory
Ph.D., Physics, State University of New York, Stony Brook
Stephen Rinehart******
Astrophysicist, NASA Goddard Space Flight Center
Ph.D., Physics, Cornell University
Steve Rissing
Professor, Department of Evolution, Ecology, and Organismal Biology, Ohio State University
Ph.D., Zoology, University of Washington, Seattle
Director, Introductory Biology Program
Stephen John Roberts
Chief Executive Officer, Witham Pty Ltd
Ph.D., Physical Organic Chemistry, Imperial College London
Justice of the Peace
Stephen P. Roberts**
Assistant Professor of Biological Sciences, University of Nevada, Las Vegas
Ph.D., Biology, Arizona State University
Stephen Robertson*
Professor of Information Systems, City University London
Researcher, Microsoft Research, Cambridge
Ph.D., Information Science, University College London
Steven Robinow**
Professor of Zoology, University of Hawai’i
Ph.D., Biology, Brandeis University
Stephen D. Robinson***
Assistant Professor of Geology, St. Lawrence University
Ph.D., Physical Geography, McGill University
Steve Robinson*******
Research Scientist, Saskatoon Research Centre, Agriculture and Agri-Food Canada
Ph.D., Genetics, University of Newcastle
Steven M. Roels*
Senior Scientist, Computational Biology, Millennium Pharmaceuticals, Inc.
Ph.D., Biology, Harvard University
Etienne B. Roesch*******
Centre for Integrative Neuroscience and Neurodynamics, University of Reading
Ph.D., Affective Sciences, University of Geneva
Author, “Psychophysics of emotion: The QUEST for emotional attention,”Journal of Vision 2010; 10(3).
Stephen Rogers****
Assistant Professor of Biology, University of North Carolina, Chapel Hill
Ph.D., Cell Biology, University of Illinois, Urbana-Champaign
Stephen Rogerson*******
Professor, Department of Medicine, University of Melbourne
Ph.D., Medical Biology, University of Melbourne
Steven R. Rogg*******
Associate Professor of Science Education, Aurora University
Ph.D., Curriculum and Instruction, Biology Education, Purdue University
Steven H. Rogstad
Professor of Biology, University of Cincinnati
Ph.D., Biology, Harvard University
Published over 30 papers on plant systematics and population biology
Steven L. Rolston******
Professor of Physics and Co-director, Joint Quantum Institute, University of Maryland, College Park
Ph.D., Physics, State University of New York, Stony Brook
Fellow of the American Physical Society
Stephanie S. Romañach******
Research Associate, Tropical Resource Ecology Programme, University of Zimbabwe
Ph.D., Ecology, University of California, Santa Barbara
Stéphane Rondenay****
Assistant Professor of Seismology, Massachusetts Institute of Technology
Ph.D., Geophysics, University of British Columbia
Steve Roof*
Assistant Professor of Earth and Environmental Science, Hampshire College
Ph.D., Geology, University of Massachusetts, Amherst
Stephen Roscoe******
Research Specialist, 3M
Ph.D., Chemistry, Northwestern University
Stephen A. Rose*
Senior Research Fellow, Molecular Medicine, University of Leeds
Ph.D., Molecular Immunology, University of Leeds
Steven Rose
Professor of Biology and Director, Brain and Behaviour Research Group, The Open University
Ph.D., ?, ?
Steven Rosenberg*****
Chief Scientific Officer, CardioDx
Ph.D., Biochemistry, University of California, Berkeley
Stephen Roser*
Senior Lecturer in Chemistry, University of Bath
Ph.D., Chemistry, Oxford University
Stephen T. Ross
T. W. Bennett Jr. Distinguished Professor in the Sciences and Curator of Fishes, University of Southern Mississippi
Ph.D., Biology, University of South Florida
Author, Inland Fishes of Mississippi
Stephen J. Rossiter******
Royal Society Research Fellow, School of Biological and Chemical Sciences, Queen Mary, University of London
Ph.D., Zoology, University of Bristol
Stephen M. Roth*
Assistant Professor of Exercise Physiology, University of Maryland
Ph.D., Kinesiology, University of Maryland
Stephen Rothman
Professor of Physiology, University of California, San Francisco
Ph.D., Physiology, University of Pennsylvania
Author, Lessons from the Living Cell
Stephen I. Rothstein
Professor of Zoology, University of California, Santa Barbara
Ph.D., Biology, Yale University
Recipient, Brewster Award (top award of the American Ornithologists Union)
Steve Rounsley*
Associate Research Professor, BIO5 Institute and Department of Plant Sciences, University of Arizona
Ph.D., Biology, University of California, San Diego
Stephen M. Rowland
Professor of Geology, University of Nevada, Las Vegas
Ph.D., Geology, University of California, Santa Cruz
Member, Paleontological Society, Geological Society of America
Steve Rowley**
Principal Scientist, Bioinformatics, Aventis Pharmaceuticals
Ph.D., Physics, Massachusetts Institute of Technology
Stephen Rudd******
Adjunct Professor of Plant Genomics, University of Turku
Ph.D., Plant Molecular Biology, University of East Anglia
Steven W. Runge*
Professor of Biology, and Dean, College of Natural Sciences and Mathematics, University of Central Arkansas
Ph.D., Biochemistry, Ohio State University
Stephen C. Ruppel******
Senior Research Scientist, Bureau of Economic Geology, John A. and Katherine G. Jackson School of Geosciences, University of Texas at Austin
Ph.D., Geology, University of Tennessee
Steve Russell******
Lecturer, Department of Genetics, Cambridge University
Ph.D., Genetics, University of Glasgow
Steven C. Sahyun******
Assistant Professor of Physics, University of Wisconsin, Whitewater
Ph.D., Physics, Oregon State University
Steve Salisbury*
Postdoctoral Research Fellow, Department of Zoology and Entomology, University of Queensland
Ph.D., Vertebrate Paleontology and Evolution, University of New South Wales
Tapani Salmi***
Head, Department of Clinical Neurophysiology, Helsinki University Hospital
Ph.D., Medical Sciences (Clinical Neurophysiology), Helsinki University
Steven L. Salzberg
Professor of Computer Science and Biology, Johns Hopkins University, and Senior Director of Bioinformatics, The Institute for Genomic Research
Ph.D., Computer Science, Harvard University
Coauthor on the scientific paper describing the human genome
Steven M. Samuels****
Associate Professor, Department of Behavioral Sciences and Leadership, United States Air Force Academy
Ph.D., Psychology, Stanford University
2001-2002 Fellow at The Center for Professional Military Ethics
Steve B. Sands**
Associate Research Fellow, Pfizer Global Research & Development
Ph.D., Physiology, University of California, Irvine
Stephen Sarre******
Associate Professor, Institute for Applied Ecology, University of Canberra
Ph.D., Population Biology, Australian National University
Steve Saunders*
Discipline Scientist, Planetary Geology and Geophysics Program, NASA
Ph.D., Geology, Brown University
Stephen G. Saupe
Professor of Biology, College of St. Benedict and St. Johns University
Ph.D., Botany, University of Illinois, Urbana Champaign
Stephen H. Savage*******
IT Manager, Archaeological Research Institute, and Affiliated Professor, School of Human Evolution & Social Change, Arizona State University
Ph.D., Anthropology, Arizona State University
Lead author, “Prospects and Problems in the Use of Hyperspectral Imagery for Archaeological Remote Sensing: A Case Study from the Faynan Copper Mining District, Jordan,” Journal of Archaeological Science 2012; 39:407-420.
Stephen W. Schaeffer
Associate Professor of Biology, Pennsylvania State University
Ph.D., Genetics, University of Georgia
Steven D. Schafersman
Senior Lecturer, University of Texas, Permian Basin
Ph.D., Geology, Rice University
Stephen F. Schaffner*
Computational Biologist, Whitehead/MIT Center for Genome Research
Ph.D., Physics, Yale University
Steven Jay Scheinman*
Professor of Medicine and Pharmacology and Chief of Nephrology, State University of New York Upstate Medical University
M.D., Yale University
Steven Jay Scher*
Professor of Psychology, Eastern Illinois University
Ph.D., Social Psychology, Princeton University
Coeditor, Evolutionary Psychology: Alternative Approaches
Steven Scherer******
William N. Kelley Professor, Department of Neurology, University of Pennsylvania School of Medicine
Ph.D., Neurology, and M.D., University of Michigan
Steven M. Schildcrout*
Professor of Chemistry, Youngstown State University
Ph.D., Physical Chemistry, Northwestern University
Stephan Q. Schneider*
Senior Postdoctoral Researcher, Institute for Molecular Biology, University of Oregon
Ph.D., Developmental Biology, Max Planck Institute
Stephen E. Schneider
Professor of Astronomy, University of Massachusetts
Ph.D., Astronomy, Cornell University
Recipient, Trumpler Award for outstanding astronomy thesis
Stephen H. Schneider †
Professor of Biological Sciences, Stanford University
Ph.D., Plasma Physics/Mechanical Engineering, Columbia University
Recipient, MacArthur Foundation Prize Fellowship (1992), the AAAS/Westinghouse Award for advancing the public understanding of science (1992); member, National Academy of Sciences; founder and editor of the journal Climatic Change
Stefan Schnitzer
Assistant Professor of Biological Sciences, University of Wisconsin, Milwaukee
Ph.D., Ecology and Evolutionary Biology, University of Pittsburgh
Stephan J. Schoech
Assistant Professor of Biology, University of Memphis
Ph.D., Zoology, University of Washington
Stephen Scholz******
Assistant Professor of Philosophy and Religion, St. Augustine’s College
Ph.D., Philosophy, University of New Mexico
Steven E. Schonfeld******
Periodontist in private practice; formerly Associate Professor in the Departments of Basic Sciences and Periodontology, School of Dentistry and the Graduate School, University of Southern California
Ph.D., Cellular and Molecular Biology, University of Southern California; D.D.S., New York University
Steven M. Schrader**
Supervising Research Biologist, National Institute for Occupational Safety and Health
Ph.D., Reproductive Physiology, University of Missouri
Steven Schultz*****
Assistant Scientific Editor, Science of Synthesis, Thieme Chemistry, George Thieme Verlag KG
Ph.D., Organometallic Chemistry, University of Münster
Stephan Schulz*
CALCULEMUS Fellow, RISC-Linz, Johannes Kepler University
Ph.D. (Dr.rer.nat), Computer Science, Technische Universität München
Author of the Equational Theorem Prover E, http://www4.informatik.tu-muenchen.de/~schulz/WORK/eprover.html
Stephen R. Schutter*
Geologist, Murphy Exploration and Production International
Ph.D., Geology, University of Iowa
Stephen M. Schwartz
Professor of Pathology, University of Washington
M.D., Boston University; Ph.D., ?, University of Washington
Steve Schwartz
Assistant Professor of Zoology, Oklahoma State University
Ph.D., Life Sciences, University of Nebraska, Lincoln
Steve Scofield*
Adjunct Assistant Professor of Agronomy, Purdue University
Ph.D., Molecular, Cellular, and Developmental Biology, Indiana University, Bloomington
Stephen Scott******
Senior Teaching Fellow, Department of Zoology, University of Otago
Ph.D., Zoology, University of Otago
Stephen H. Scott******
Professor, Department of Anatomy and Cell Biology and Department of Medicine, Queen’s University
Ph.D., Physiology, Queen’s University
Stephen L. Scott*
Senior Scientist, Owens Valley Radio Observatory, California Institute of Technology
Ph.D., Applied Physics, University of California, San Diego
Stephen J. Scribner******
Registered Patent Agent, PARTEQ Innovations
Ph.D., Biology, Queen’s University
Steven Seavey
Professor and Chair of Biology, Lewis and Clark College
Ph.D., Biology, Stanford University
Stephen Secor******
Associate Professor, Department of Biological Sciences, University of Alabama
Ph.D., Biology, University of California, Los Angeles
Steven E. Seifried*****
Associate Professor of Cell and Molecular Biology, John A. Burns School of Medicine, University of Hawai’i
Ph.D., Biochemistry, University of Wisconsin, Milwaukee
Steven M. Seiler******
Adjunct Professor of Biology, University of Wisconsin, Stevens Point
Ph.D., Biology, Idaho State University
Steven Selden
Professor of Education, University of Maryland, College Park
Ed.D., Education, Columbia University Teachers College
Author, Inheriting Shame: The Story of Eugenics and Racism in America
Stephen J. Seligman*
Research Professor, Department of Microbiology and Immunology, New York Medical College
M.D., New York University
Steven Semken
Assistant Professor, School of Earth and Space Exploration, Arizona State University
Ph.D., Materials Science, Massachusetts Institute of Technology
Past president, National Association of Geoscience Teachers
Steve Seredick******
Post-Doctoral Researcher, Institute of Neuroscience, University of Oregon
Ph.D., Microbiology and Immunology, University of British Columbia
Stephen Serjeant***
Lecturer in Astrophysics, University of Kent
D.Phil., Astrophysics, Oxford University
Steven G. Sethofer*******
Postdoctoral Researcher, University of California, San Francisco
Ph.D., Chemistry, University of California, Berkeley
Lead author, “Gold(I)-Catalyzed Enantioselective Polycyclization Reactions,”Journal of the American Chemical Society (2010), 132, 8276-8278
Steven Shackley
Research Archaeologist and Adjunct Professor, Phoebe Hearst Museum of Anthropology, University of California, Berkeley
Ph.D., Anthropology, Arizona State University
Author, Archaeological Obsidian Studies: Method and Theory
Steven M. Shapiro*****
Professor of Neurology, Pediatrics, Otolaryngology, Physiology, and PM&R; Vice Chairman of Child Neurology, Division of Child Neurology; Director, Clinical Fellowship Program and Intraoperative Neurophysiological Monitoring, Division of Clinical Neurophysiology, Department of Neurology, Virginia Commonwealth University Medical Center, Virginia Commonwealth University
M.D., University of Pittsburgh
Steve D. Sharples***
Research Fellow, School of Electrical & Electronic Engineering, University of Nottingham
Ph.D., Applied Optics, University of Nottingham
J. Stephen Shaw******
M.D., Harvard Medical School
Coauthor, “Phospholipase C-mediated hydrolysis of PIP2 releases ERM proteins from lymphocyte membrane,” Journal of Cell Biology 2009; 184: 451-62.
Steven R. Shaw******
Assistant Professor, Department of Educational and Counselling Psychology, and Director, Resilience, Pediatric Psychology, and Neurogenetic Connections Lab, McGill University
Ph.D., Educational Psychology, University of Florida
Stephen J. Shawl
Professor of Physics and Astronomy, University of Kansas
Ph.D., Astronomy, University of Texas, Austin
Coauthor, Discovering Astronomy
Stephen D. Shea*******
Assistant Professor in Neuroscience, Cold Spring Harbor Laboratory
Ph.D., Neurobiology, University of Chicago
Steve Sheffield*
Affiliate Professor of Environmental Science and Policy, George Mason University
Ph.D., Zoology, Oklahoma State University
Stephen Shennan
Professor of Theoretical Archaeology and Director of the AHRB Centre for the Evolutionary Analysis of Cultural Behaviour, University College London
Ph.D., Archaeology, Cambridge University
Author, Genes, Memes and Human History
Steven D. Sheridan******
Senior Staff Scientist, Massachusetts General Hospital, Harvard Medical School
Ph.D., Molecular Biology and Biochemistry, University of California, Irvine
Steven Sherwood
Assistant Professor of Geophysics, Yale University
Ph.D., Oceanography, Scripps Institution of Oceanography
Recipient, 2005 Clarence Leroy Meisinger Award from the American Meteorological Society
Steven K. Shevell******
Eliakam Hastings Moore Distinguished Service Professor, Psychology and Ophthalmology & Visual Science, University of Chicago
Ph.D., Mathematical Psychology, University of Michigan
Past President (2008), Vision Sciences Society`
Steven C. Shivers****
Associate Director for Translational Research, Lakeland Regional Cancer Center
Ph.D., Medical Sciences, University of South Florida College of Medicine
Coauthor, “Workshop on Cancer Biometrics: Identifying Biomarkers and Surrogates of Cancer in Patients: A Meeting Held at the Masur Auditorium, National Institutes of Health,” Journal of Immunotherapy 2005 March/April; 28 (2): 79-119.
Steven E. Shoelson******
Section Head, Cellular & Molecular Physiology, Joslin Diabetes Center, and Professor of Medicine, Harvard Medical School
M.D., Ph.D., Chemistry, University of Chicago
Recipient, Burroughs Wellcome Fund Scholar Award in Experimental Therapeutics
Stephen B. Shope
Adjunct Clinical Professor of Optometry, University of Houston
Ph.D., Neuroscience, University of Texas Medical Branch at Galveston; O.D., New England College of Optometry
Steve Shore****
Professor of Chemistry, Oklahoma City Community College
Ph.D., Chemistry, University of Oklahoma
Steven N. Shore***
Professore Ordinario Astrofisica, Università di Pisa
Ph.D., Astronomy/Astrophysics, University of Toronto
Associate Editor, Astronomy and Astrophysics
Stephen J. Short******
Post-Doctoral Researcher, Scripps Institution of Oceanography, University of California, San Diego
Ph.D., Microbiology, University of Portsmouth
Steven M. Short****
Assistant Professor, Department of Biology, University of Toronto, Mississauga
Ph.D., Botany, University of British Columbia
Stephen M. Shuster
Professor of Invertebrate Zoology, Northern Arizona University
Ph.D., Zoology, University of California, Berkeley
Coauthor, Mating Systems and Strategies
Steven Siciliano**
Assistant Professor of Soil Ecotoxicology, University of Saskatchewan
Ph.D., Toxicology, University of Saskatchewan
Stephen C. Sillett
Associate Professor of Biological Sciences, California State University, Humboldt
Ph.D., Botany, Oregon State University
Stephanie A. Navarro Silvera*****
Assistant Professor, Department of Health and Nutrition Sciences, Montclair State University
Ph.D., Epidemiology and Public Health, Yale University
Coauthor, “Carotenoid, vitamin A, vitamin C, and vitamin E intake and risk of ovarian cancer: A prospective cohort study,” Cancer Epidemiology Biomarkers & Prevention 2006 Feb; 15 (2): 395-397.
Steven Simensky******
General Neurologist, Columbus Neurology and Neurosurgery
M.D., University of Vermont; Ph.D., Exercise Science, Michigan State University
Stephen J. Simpson
Professor of the Hope Entomological Collections, Oxford University
Ph.D., Entomology, Kings College London
Steven P. Sinkins******
Wellcome Trust Senior Research Fellow, Oxford University
Ph.D., Molecular Genetics, University of London
Steve Sivier*****
Engineer, Sun Microsystems
Ph.D., Aerospace Engineering, University of Illinois, Urbana
Steven C. Slater****
Associate Professor, Biodesign Institute and School of Life Sciences, Arizona State University
Ph.D., Molecular Microbiology, Case Western Reserve University
Stephen T. Smale
Professor of Microbiology, Immunology and Molecular Genetics, University of California, Los Angeles
Ph.D., Biochemistry, University of California, Berkeley
Steven L. Small****
Professor of Neurology and Psychology, University of Chicago
Ph.D., Computer Science, University of Maryland; M.D., University of Rochester
Coauthor, “Listening to talking faces: Motor cortical activation during speech perception,” Neuroimage 2005; 25 (1): 76-89.
Stephen J. Smith
Professor of Molecular and Cellular Physiology, Stanford University School of Medicine
Ph.D., Physiology and Psychology, University of Washington
Stephen M. Smith******
Professor of Biomedical Engineering, Department of Clinical Neurology, Oxford University
D.Phil., Computer Vision, Department of Engineering Science, Oxford University
Stephen S. Smith****
Senior Scientist, Lexicon Genetics
Ph.D., Physiology, University of Michigan
Steve Smith******
Post-Doctoral Researcher, Research Institute of Wildlife Ecology, Vienna
Ph.D., Conservation Genetics, Griffith University
Steve E. Smith*
Director, Research and Development, ACE Tempest Reinsurance Ltd.
D.Phil., Atmospheric Physics, Oxford University
Steven J. Smith*****
Senior Scientist, Xenogen Corporation
Ph.D., Microbiology, North Carolina State University
Steven J. Smith*******
Post-Doctoral Fellow, HIV Drug Resistance Program, National Cancer Institute, National Institutes of Health
Ph.D., Molecular and Cellular Biochemistry, University of Kentucky
Steven O. Smith*****
Professor of Biochemistry and Cell Biology and Director, Center for Structural Biology, Stony Brook University
Ph.D., Chemistry, University of California, Berkeley
Steven Thomas Smith*
Senior Technical Staff, Lincoln Laboratory, Massachusetts Institute of Technology
Ph.D., Applied Mathematics, Harvard University
Senior Member of IEEE; recipient, SIAM outstanding paper prize; listed inWho’s Who in America, Who’s Who in Science and Engineering
Steven L. Snowden******
Astrophysicist, NASA/Goddard Space Flight Center
Ph.D., Physics, University of Wisconsin, Madison
Stephen So******
Post-doctoral Research Associate, Department of Electrical Engineering, Princeton University
Ph.D., Electrical and Computer Engineering, Rice University
Coauthor, “Exhaled human breath analysis with quantum cascade laser based gas sensors” in Breath Analysis for Clinical Diagnosis and Therapeutic Monitoring (World Scientific, 2005): pp. 75-84.
Stephanie Sobek******
Postdoctoral Fellow, Department of Biology, University of Western Ontario
Ph.D., Biodiversity and Ecology, University of Göttingen
Stefan Sommer
Director of the Natural Heritage Center, Research Assistant Professor, Idaho State University
Ph.D., Biology, University of New Mexico
Executive producer, “Treasuring Our Natural Heritage”
Stephanie Rena Songer*
Assistant Professor of Biology, Concord College
Ph.D., Neuroscience, Emory University
Steven D. Sorden****
Associate Professor, College of Veterinary Medicine, Iowa State University
Ph.D., Pathology, University of Wisconsin, Madison
Diplomate, American College of Veterinary Pathologists
Steven P. Souza*
Observatory Supervisor and Instructor in Astronomy, Williams College
Ph.D., Astronomy, State University of New York at Stony Brook
Stephen Spiegelberg***
President, Cambridge Polymer Group, Inc.
Ph.D., Chemical Engineering, Massachusetts Institute of Technology
Inventor of crosslinked UHMWPE for total hip and knee replacement
Stephen Spiro**
Associate Professor of Biology, Georgia Institute of Technology
Ph.D., Biology, University of Sheffield
Stephen Sprang
Professor of Biochemistry, University of Texas Southwestern Medical Center, Investigator, Howard Hughes Medical Institute
Ph.D., Biochemistry, University of Wisconsin, Madison
Fellow, American Association for the Advancement of Science
Stephen John Sque*****
Post-Doctoral Research Assistant, Theoretical Semiconductor Physics Group, University of Exeter
Ph.D., Physics, University of Exeter
Steven W. Squyres******
Goldwin Smith Professor of Astronomy, Cornell University
Ph.D., Planetary Sciences, Cornell University
Principal Investigator for NASA’s Mars Exploration Rover mission
Steven St. John******
Associate Professor, Department of Psychology, Rollins College
Ph.D., Psychology, University of Florida
Stephen M. Stack**
Professor of Biology, Colorado State University
Ph.D., Botany, University of Texas, Austin
Stephen D. Stahl
Vice President for Academic Affairs & Dean of the College, Sweet Briar College
Ph.D., Geology, Northwestern University
Stephen E. Stancyk*
Professor of Marine Science and Biological Sciences, University of South Carolina
Ph.D., Zoology, University of Florida
Editor, Reproductive Ecology of Marine Invertebrates
Steven M. Stanley
Professor of Earth and Planetary Sciences, Johns Hopkins University
Ph.D., Paleontology, Yale University
Member of the National Academy of Sciences
Stephen C. Stearns
Professor of Ecology and Evolution, Yale University
Ph.D., Zoology, University of British Columbia
Author, The Evolution of Life Histories, Evolution in Health and Disease,Evolution: An Introduction; cofounder, European Society for Evolutionary Biology, Journal of Evolutionary Biology, Tropical Biology Association
Steven L. Stephenson*****
Research Professor, Department of Biological Sciences, University of Arkansas
Ph.D., Botany, Virginia Polytechnic Institute and State University
Steve Stewart-Williams***
Post-Doctoral Research Fellow, Department of Psychology, McMaster University
Ph.D., Psychology, Massey University
Coauthor, “The Placebo Effect: Dissolving the Expectancy vs. Conditioning Debate,” Psychological Bulletin 2004; 130 (2): 324-340
Stephen P. Stich
Board of Governors Professor of Philosophy, Rutgers University
Ph.D., Philosophy, Princeton University
Stephen Stockton*****
Chief Executive Officer, Naturestock Environmental
Ph.D., Biology, University of Ottawa
Steve Storm****
Assistant Professor of Mathematics and Science, Arkansas State University, Heber Springs
Ph.D., Physics and Mathematics, Baylor University
Awarded the Presidential Award for Excellence in Science Teaching
Steve Stowers
Postdoctoral Fellow, ?, University of California, Berkeley
Ph.D., Biochemistry, Stanford University School of Medicine
Stefan Strack
Assistant Professor of Pharmacology, University of Iowa
Ph.D., Biology, State University of New York, Albany
H. Stephen Straight*****
Professor of Anthropology; Professor of Linguistics; Vice Provost for Undergraduate Education & International Affairs, State University of New York, Binghamton
Ph.D., Linguistics, University of Chicago
Stephen M. Strakowski******
The Stanley and Mickey Kaplan Professor and Chair of Psychiatry, Professor of Psychology and Biomedical Engineering, and Director, Center for Imaging Research, University of Cincinnati
M.D., Vanderbilt University School of Medicine
Steve Strand
Director, UCLA Ocean Discovery Center, University of California, Los Angeles
Ph.D., Marine Biology, University of California, Davis
Steve Strassmann*
Principal Researcher, Orange SA
Ph.D., Media Arts and Sciences, Massachusetts Institute of Technology
Steve Strauss
Professor of Forest Science, Oregon State University
Ph.D., Wildland Resource Science, University of California, Berkeley
Author of more than 100 publications in genetics and forest biology
Stephen A. Stricker
Associate Professor and Director of Electron Microscopy, University of New Mexico
Ph.D., Zoology, University of Washington
Steve Strogatz***
Professor of Theoretical and Applied Mechanics, Cornell University
Ph.D., Applied Mathematics, Harvard University
Author, Sync: The Emerging Science of Spontaneous Order
Stephanie Suhr******
Assistant to the Management Board, European X-ray Free-Electron Laser (XFEL)
Ph.D., Oceanography (Benthic Biology), University of Southampton
Steven A. Sullivan*
IRTA Fellow, National Center for Biotechnology Information
Ph.D., Anatomy & Cell Biology/Cell, Developmental & Neural Biology, University of Michigan
Steven D. Sundbeck***
ASEE-NRL Postdoctoral Fellow, Naval Research Laboratory
Ph.D., Physics, University of Chicago
Steve Suter******
Professor of Psychology and University Research Ethics Review Coordinator, California State University, Bakersfield
Ph.D., Experimental Psychology, The Johns Hopkins University
Steven Sutlief******
Affiliate Instructor, Radiation Oncology, University of Washington
Ph.D., Physics, University of Washington
Staffan J. Svärd******
Research Engineer, Department of Neutron Research, Uppsala University
Ph.D., Physics, Uppsala University
Stephen E. Swearer*******
Associate Professor of Marine Biology, University of Melbourne
Ph.D., Biological Sciences, University of California, Santa Barbara
Steven Swoap****
Associate Professor of Biology, Williams College
Ph.D., Physiology and Biophysics, University of California at Irvine
Steven M. Taffet*
Professor of Microbiology, State University of New York Upstate Medical University
Ph.D., Microbiology and Immunology, University of North Carolina, Chapel Hill
Stephanie Tai*****
Visiting Professor of Law, Washington and Lee University School of Law
Ph.D., Chemistry, Tufts University; J.D., Georgetown University Law Center
Steven Tait***
Business Manager, MRC Technology
Ph.D., Medical Microbiology, University of Edinburgh
Steven L. Tanimoto*******
Professor of Computer Science and Engineering, University of Washington
Ph.D., Electrical Engineering, Princeton University
Author, Introduction to Python for Artificial Intelligence (IEEE Computer Society, 2008)
Stephen J. Tapscott
Member, Human Biology Division and Clinical Research, Fred Hutchinson Cancer Research Center
Ph.D., Anatomy, and M.D., University of Pennsylvania School of Medicine
Stephen J. Tatman****
Consultant
Ph.D., Micropaleontology, University of Wales, Aberystwyth
Coauthor, “A new genus of Ostracoda of the Family Limnocytheridae from the non-marine Mid-Cretaceous of Alberta, Canada,” Revue de Micropaléontologie 2001; 44(1): 93-102.
Stephen Taylor******
Professor of Physical and Earth Sciences, Kauai Community College
Ph.D., Physical Oceanography, Scripps Institution of Oceanography / University of California, San Diego
Steve Taylor*
Associate Research Scientist, Center for Biodiversity, Illinois Natural History Survey
Ph.D., Zoology, Southern Illinois University, Carbondale
Stephen Harrold Tedder*
Engineering Specialist, American Airlines
Ph.D., Chemistry, University of Texas, Austin
Stephen Teitel*****
Professor of Physics, University of Rochester
Ph.D., Physics, Cornell University
Fellow, American Physical Society
Stephen Temperley
Lecturer in Structural Geology, University of Leicester
Ph.D., Geology, University of Hull
Fellow of the Geological Society
Stephen M. Theberge*
Assistant Professor of Chemistry and Co-Director of Environmental Science, Merrimack College
Ph.D., Chemistry, University of Delaware
Steven D. Theiss****
Research Specialist, 3M
Ph.D., Applied Physics, Harvard University
Stephen T. Thibault******
Protein Chemist, Amgen, Inc.
Ph.D., Entomology, University of California, Riverside
Stephen W. Thiel***
Research Associate Professor of Chemical Engineering, University of Cincinnati
Ph.D., Chemical Engineering, The University of Texas at Austin
Licensed Professional Engineer, State of Ohio
J. Steve Thomas***
Assistant Professor of Biology, Tennessee State University
Ph.D., Neurophysiology, Indiana University
Stephen J. Thomas*******
Ph.D., Experimental Psychology, University of Iowa
Stephen R. Thomas******
Visiting Assistant Professor of Zoology, Michigan State University
Ph.D., Organismic and Evolutionary Biology and Entomology, University of Massachusetts, Amherst
Stefan Thor
Associate Professor of Neurobiology, Harvard Medical School
Ph.D., Molecular Biology, Umea University
Stephen Thorsett*
Professor of Astronomy and Astrophysics, University of California, Santa Cruz
Ph.D., Physics, Princeton University
Stephen S. Tillett******
Investigador Titular Jubilado Activo, Herbario Dr. Víctor Manuel Ovalles, Facultad de Farmacia, Universidad Central de Venezuela
Ph.D., Botany, Claremont Graduate School
Author, “Passifloraceae,” pp. 625-667 in Flora of the Venezuelan Guayana Vol. 7. Myrtaceae-Plumbaginaceae, P. E. Berry, K. Yatskievych, and B. Holst, eds. (St. Louis: Missouri Botanical Garden Press, 2003). ”
Stephen G. Tilley
Myra A. Sampson Professor of Biological Sciences, Smith College
Ph.D., Zoology, University of Michigan
Steven Timbrook**
Executive Director, Ganna Walska Lotusland Foundation
Ph.D., Biology, University of California, Santa Barbara
Stefano Tiozzo******
Postdoctoral Scholar, Institute of Stem Cell Biology and Regenerative Medicine, Stanford University
Ph.D., Evolutionary Biology, University of Padova
Stephen S. Tobe
Professor of Zoology, University of Toronto
Ph.D., Parasitology, McGill University
Fellow of the Royal Society of Canada
Stephan Tobies*******
Software Design Engineer, European Microsoft Innovation Center
Ph. D. (Dr. rer. nat.), Computer Science, Aachen University of Technology
Stephanie Toering**
Adjunct Assistant Professor of Biology, College of Saint Benedict and Saint John’s University
Ph.D., Biochemistry, Stanford University
Stephen Toner******
Senior Chemist and Development Engineer, Teledyne Advanced Pollution Instrumentation
Ph.D., Chemistry, University of California, San Diego
Stephen J. Tonsor****
Associate Professor, Department of Biological Sciences, University of Pittsburgh
Ph.D., Biology, University of Chicago
Stephen Tooth***
Lecturer, Institute of Geography and Earth Sciences, University of Wales, Aberystwyth
Ph.D., Physical Geography, University of Wollongong
Coauthor, “Forms and processes of two highly contrasting rivers in arid central Australia, and the implications for channel-pattern discrimination and prediction,” Geological Society of America Bulletin (2004); 116 (7-8): 802-816
Stephen T. Toy**
Instructor, Academy of Lifelong Learning, University of Delaware
Ph.D., Microbiology, University of Florida
Formerly conducted teaching and research in virology and immunology at Case Western Reserve University and Thomas Jefferson University; formerly conducted research in immunology at DuPont Pharmaceuticals
Stefan Trapp******
Senior Lecturer, Faculty of Medicine, Imperial College London
Ph.D., Biology, Universität Göttingen
Steven E. Travers*
Assistant Professor of Biological Sciences, North Dakota State University
Ph.D., Plant Evolutionary Ecology, University of California, Santa Barbara
Steven E. Travis******
Associate Professor of Biology, University of New England
Ph.D., Biology, Northern Arizona University
Coauthor, “Disentangling the role of hybridization in the evolution of the endangered Arizona cliffrose (Purshia subintegra; Rosaceae): a molecular and morphological analysis,” Conservation Genetics (2008) 9: 1183-1194.
Steven A. Trewick******
Senior Lecturer, Institute of Natural Resources, Massey University
Ph.D., Zoology, Victoria University of Wellington
Co-author, “Hello New Zealand,” Journal of Biogeography 2007; 34: 1-6.
Steve Trigwell****
Research Scientist, Electrostatics and Surface Physics Laboratory, NASA Kennedy Space Center
Ph.D., Applied Science/Materials Engineering, University of Arkansas at Little Rock
Stephen Trimberger***
Director of Advanced Development, Xilinx Research Labs
Ph.D., Computer Science, California Institute of Technology
Stephanie Tristram-Nagle
Research Professor, Department of Physics, Carnegie Mellon University
Ph.D., Comparative Biochemistry, University of California, Berkeley
Recipient, 2003 Avanti Award in Phospholipids from the Biophysical Society
Stephen C. Trombulak
Professor of Biology and Environmental Studies, Middlebury College
Ph.D., Zoology, University of Washington
Coauthor, The Story of Vermont: A Natural and Cultural History
Stephen Trowell***
Principal Research Scientist, CSIRO Entomology
Ph.D., Biochemistry, Australian National University
Stephen J. Trumble*
Animal Physiologist, Department of Biology Baylor University
Ph.D., Marine Biology, University of Alaska, Fairbanks
Stephen T. Trumbo
Assistant Professor of Ecology and Evolutionary Biology, University of Connecticut
Ph.D., Biology, University of North Carolina
Stephen J. Tucker******
Fellow of Green Templeton College and University Lecturer in Biological Physics, Oxford University
D.Phil., Biochemistry, Oxford University
Stephen W. Tuholski*
Assistant Professor of Psychology, Southern Illinois University Edwardsville
Ph.D., Experimental Psychology, University of South Carolina
Steven Turley*****
Professor, Department of Physics and Astronomy, and Associate Dean of Undergraduate Education, Brigham Young University
Ph.D., Physics, Massachusetts Institute of Technology
President-Elect, Utah Academy of Sciences, Arts, and Letters
Stephen H. Unger*****
Professor of Computer Science, Columbia University
Sc.D., Electrical Engineering, Massachusetts Institute of Technology
Fellow, American Association for the Advancement of Science, Institute of Electrical and Electronics Engineers; author, Controlling Technology: Ethics and the Responsible Engineer
Stefan Ungricht***
Systematic Botanist, Institut für Systematische Botanik, Universität Zürich
Ph.D., Ecological and Evolutionary Biology, Université Montpellier II
Stephen D. Unwin****
President, Unwin Company, Inc.
Ph.D., Theoretical Physics, University of Manchester
Author, The Probability of God
Steve J. Upton******
Professor of Biology, Kansas State University
Ph.D., Zoology/Entomology, Auburn University
Stephen Urquhart*
Assistant Professor of Chemistry, University of Saskatchewan
Ph.D., Chemistry, McMaster University
Stephen Garrett Vail*
Associate Professor of Biology, William Paterson University
Ph.D., Ecology, University of California, Davis
Steve Vallerand****
Director, Quebec Marine Mammal Emergency Response Network Call Center
Ph.D., Computer Engineering, Nara Institute of Science and Technologies
Member, Group of Research and Education on Marine Mammals
Steven M. Vamosi
Assistant Professor of Biological Sciences, University of Calgary
Ph.D., Zoology, University of British Columbia
Steve Vance******
Scientist, Jet Propulsion Laboratory, California Institute of Technology
Ph.D., Geophysics and Astrobiology, University of Washington, Seattle
Lead author, “Hydrothermal Systems in Small Ocean Planets,” Astrobiology2007, 7 (6): 987-1005
Stephen J. Van der Hoven******
Assistant Professor, Department of Geography-Geology, Illinois State University
Ph.D., Geology and Geophysics, University of Utah
Steve Van Dyck******
Senior Curator of Vertebrates, Queensland Museum
Ph.D., Zoology, University of New South Wales
Editor, Mammals of Australia, third edition
Steve Vander Wall
Associate Professor of Biology, University of Nevada, Reno
Ph.D., Ecology, Utah State University
Author, Food Hoarding in Animals
Stephen Van Hooser******
Research Associate, Duke University Medical Center
Ph.D., Neuroscience, Brandeis University
Steve Verhey*
Associate Professor of Biology, Central Washington University
Ph.D., Botany & Plant Pathology, Oregon State University
Organizer of first Annual Darwin Day Celebration at Central Washington University
Stephen J. Vermette*******
Professor of Geography, Buffalo State College
Ph.D., Geography, McMaster University
Stephanie Vernooy*****
Adjunct Faculty, Natural Sciences, Pasadena City College
Ph.D., Biology, California Institute of Technology
Steven E. Vigdor*
Professor of Physics, Purdue University
Ph.D., Physics, University of Wisconsin, Madison
Fellow of the American Physical Society
Steven B. Vik
Professor of Biological Sciences, Southern Methodist University
Ph.D., Chemistry, University of Oregon
Stephen P. Vives*
Professor of Biology and Department Chair, Georgia Southern University
Ph.D., Zoology, University of Wisconsin, Madison
Steven C. Vlad*****
Rheumatology Fellow, Boston University Medical Center
M.D., University of Iowa College of Medicine; D.Sc., Epidemiology (in progress), Boston University School of Public Health
Steven Vogel
James B. Duke Professor of Biology, Duke University
Ph.D., Biology, Harvard University
Winner, Irving and Jean Stone Prize for Science Writing for Public Understanding; author, Cats’ Paws and Catapults: Mechanical Worlds of Nature and People
Steven A. Vokes*******
Assistant Professor, Section of Molecular Cell & Developmental Biology, Institute for Cellular & Molecular Biology, University of Texas, Austin
Ph.D., Molecular Biology, University of Texas, Austin
Steve Wade******
Senior Lecturer in Information Systems, School of Computing and Engineering, University of Huddersfield
Ph.D., Computing, University of Sheffield
Stephen M. Wagener****
Associate Professor of Biology and Environmental Sciences, Western Connecticut State University
Ph.D., Soil Ecology, University of Alaska, Fairbanks
Steven J. Wagstaff******
Scientist, Allan Herbarium, Landcare Research
Ph.D., Botany, Ohio University
Coauthor, “Evolution and biogeography of Lyallia and Hectorella (Portulacaceae), geographically isolated sisters from the Southern Hemisphere,” Antarctic Science 2007; 19: 417-426.
Stephan R. Walk*******
Professor of Kinesiology, California State University, Fullerton
Ph.D., Kinesiology, Michigan State University
Author, “Pain and injury in sport,” pp. 205-214 in W. E. Garret, D. T. Kirkendall, and D. L. Squire, editors, Principles and Practice of Primary Care Sports Medicine (Lippincott Williams & Wilkins, 2001)
Stephen F. Walker*
Senior Lecturer in Psychology and Dean, Faculty of Science, Birkbeck College, University of London
Ph.D., Psychology, University of London
Steven C. Wallace******
Associate Professor, Department of Geosciences, East Tennessee State University
Ph.D., Vertebrate Paleontology, University of Iowa
Stephen Walton*
Professor of Astronomy, California State University, Northridge
Ph.D., Astronomy, University of Hawaii
Stephen Jay Warburton
Associate Professor of Biology, New Mexico State University
Ph.D., Physiology, Brown University
Steve Ware*******
Clinical Medical Physicist, Mayo Clinic of Arizona
Ph.D., Radiologic Science, University of Texas Health Science Center at San Antonio
Stephen R. Wassell
Professor of Mathematical Sciences, Sweet Briar University
Ph.D., Mathematics, University of Virginia
Steven Alexander Wasserman
Professor of Biology, University of California, San Diego
Ph.D., Biology, Massachusetts Institute of Technology
David and Lucille Packard Fellow in Science and Engineering
Steve Waters*
Scientist, Metabolex, Inc.
Ph.D., Physiology, Wayne State University
Steven F. Watkins******
Associate Professor of Chemistry, Louisiana State University
Ph.D., Chemistry, University of Wisconsin, Madison
Steve Weaver*
Professor of Geology, University of Canterbury
?
Chair, Board of Gateway Antarctica; Editor, Journal of Volcanology and Geothermal Research
Stephen Webb*
Lecturer in Physics, The Open University
Ph.D., Theoretical Physics, University of Manchester
Author, Measuring the Universe and Where is Everybody?
Stephen C. Weeks
Associate Professor of Biology, University of Akron
Ph.D., Ecology, Rutgers University
Steven Weinberg
Professor of Physics and Astronomy, University of Texas, Austin
Ph.D., Physics, Princeton University
Recipient, 1977 Nobel Prize in Physics, National Medal of Science
Stephen Weiner
Professor of Structural Biology, The Weizmann Institute of Science
Ph.D., Geobiology, California Institute of Technology
Coauthor, On Biomineralization
Steve Weinstein******
Assistant Professor of Philosophy, University of Waterloo; Affiliate, Perimeter Institute for Theoretical Physics
Ph.D., Philosophy, Northwestern University
Author, “Anthropic reasoning in multiverse cosmology and string theory,”Classical and Quantum Gravity 2006; 23: 4231-4236.
Stephen Weisberg*******
Executive Director, Southern California Coastal Water Research Project Authority
Ph.D., Biology, University of Delaware
Steve Welch******
Director, Centre for Advanced Instrumentation Systems, University College, London
Ph.D., Astrophysics, University College, London
Stephen P. Weldon*******
Assistant Professor of History of Science, University of Oklahoma
Ph.D., History of Science and American History, University of Wisconsin, Madison
Editor, Isis Current Bibliography of the History of Science
Stephen A. Wells*****
Postdoctoral Fellow, Center for Biological Physics, Arizona State University
Ph.D., Earth Sciences, Cambridge University
Coauthor, “Constrained Geometric Simulation of Diffusive Motion in Proteins,” Physical Biology 2005; 2: S127-S136.
Stephanie M. Welter*****
Assistant Professor, Department of Biological and Environmental Studies, Morehead State University
Ph.D., Biology, Indiana University
J. Stephen Wendt*******
Chief, Migratory Bird Conservation (retired), Canadian Wildlife Service
Ph.D., Biology, Carleton University
Steve Westrop****
Professor of Geology and Geophysics, and Curator of Invertebrate Paleontology, University of Oklahoma
Ph.D., Geology, University of Toronto
C. Steven Whisnant***
Professor and Department Head of Physics, James Madison University
Ph.D., Physics, Purdue University
Stephen H. White**
Professor of Physiology and Biophysics, University of California, Irvine
Ph.D., Physiology and Biophysics, University of Washington, Seattle
Past President, Biophysical Society
Steve R. White*
Senior Manager, IBM Thomas J. Watson Research Center
Ph.D., Theoretical Physics, University of California, San Diego
Coauthor, “Computer Viruses,” Scientific American
Stephen J. Whittle*******
Retired Senior Tutor in Biological Sciences, University of Greenwich
Ph.D., Botany (Biochemistry), University of London Birkbeck College
Stefanie Widder******
Post-doctoral student, Institute for Theoretical Chemistry, Vienna University
Ph.D., Genetics, Vienna University
Steven C. Wiest*
Owner, Wiest Consulting
Ph.D., Crop Science, Cornell University
Steven Wilkinson***
Senior Research Associate, University of East Anglia
Ed.D., Educational Research, Deakin University
Member, British Educational Research Association
Stephen Willett***
Senior Physicist, Health Imaging Divison, Eastman Kodak
Ph.D., Physics, Yale University
Stephen Earl Williams*****
Professor of Soil Biology and Biochemistry, University of Wyoming
Ph.D., Soil Sciences, North Carolina State University
Coauthor, Rangeland Health
Stephen R. Williams******
Programme Leader, MRC-Laboratory of Molecular Biology
Ph.D., Neuroscience, Cardiff University
Steve Williams******
Director, Centre for Tropical Biodiversity & Climate Change, James Cook University
Ph.D., Zoology, James Cook University
Author of a number of papers examining the determinants of biodiversity and the impacts of climate change
Steven P. Willner***
Astronomer, Harvard-Smithsonian Center for Astrophysics
Ph.D., Astronomy, California Institute of Technology
Former scientific editor of The Astrophysical Journal
Stephen J. Willson
Professor of Mathematics, Iowa State University
Ph.D., Mathematics, University of Michigan
Stephen W. Wilson
Professor of Biology, Central Missouri State University
Ph.D., Zoology, Southern Illinois University, Carbondale
Coauthor, “Evolutionary patterns of host plant use by delphacid planthoppers and their relatives” in Planthoppers: Their Ecology and Management
W. Stephen Wilson*
Professor and past Chair, Department of Mathematics, Johns Hopkins University
Ph.D., Mathematics, Massachusetts Institute of Technology
Steven D. Wilt*******
Associate Professor, Biology, Bellarmine University
Ph.D., Anatomical Sciences and Neurobiology, University of Louisville
Steve Wilton******
Head, Molecular Genetic Therapy, University of Western Australia
Ph.D., Molecular Biology, University of Adelaide
Stephen C. Winans******
Professor, Department of Microbiology, Cornell University
Ph.D., Biology, Massachusetts Institute of Technology
Author, “Evolution by Intelligent Design,” ACS Chemical Biology 2006; 1 (7): 429-431; coauthor, “VirA and VirG activate the Ti plasmid repABC operon, elevating plasmid copy number in response to wound-released chemical signals,” PNAS (USA) 2005; 102: 14843-14848.
Steven J. Winder******
Professor of Molecular Cell Biology, Department of Biomedical Science, University of Sheffield
Ph.D., Physiology and Biochemistry, University of Reading
Stephen Winter*******
Senior Research Specialist, Oklahoma State University
Ph.D., Natural Resource Ecology and Management, Oklahoma State University
Steven P. Wise*******
Research Biologist (retired), National Institute of Mental Health
Ph.D., Biology, Washington University in St. Louis
Stephanie Wissel*******
Postdoctoral Fellow in Science Education, Princeton Plasma Physics Laboratory
Ph.D., Physics, University of Chicago
Steven J. Wolf
Associate Professor of Botany, California State University, Stanislaus
Ph.D., Botany, University of Alberta
Stefan Leo Wolff
?, University of Munich
Ph.D., Physics, University of Munich
Stephen S. Wolff****
Technical Manager, Academic Research and Technology Initiatives, Cisco Systems
Ph.D., Electrical Engineering, Princeton University
Stephen M. Wolniak
Professor of Cell Biology and Molecular Genetics, University of Maryland, College Park
Ph.D., Botany, University of California, Berkeley
Administrator of http://www.life.umd.edu/CBMG/faculty/wolniak/wolniakmitosis.html (a popular website, visited by thousands of students looking for information about mitosis)
Stephen D. Wolpe*
Senior Director, Cell and Molecular Biology, Wellstat Therapeutics Corporation
Ph.D., Anatomy, University of Pennsylvania
Involved in the discovery and early characterization of the chemokine family of cytokines
Steve Wolverton******
Assistant Professor of Geography, University of North Texas
Ph.D., Anthropology, University of Missouri; Ph.D., Environmental Science, University of North Texas
Stephen C. C. Wong*
Experimental Officer, Manchester Interdisciplinary Biocentre, The University of Manchester
Ph.D., Chemistry, University of Manchester Institute of Science and Technology
Member, British Mass Spectrometry Society, American Society for Mass Spectrometry
Stephen A. Wood*
Staff Scientist, Thomas Jefferson National Accelerator Facility
Ph.D., Physics, Massachusetts Institute of Technology
Stephen C. Wood
Director, Mountain Research Foundation
Ph.D., Biology, University of Oregon
Member of the editorial board, American Journal of Physiology
Stephen J. Wood***
Senior Research Officer, Melbourne Neuropsychiatry Centre, University of Melbourne
Ph.D., Cognitive Neuroscience, University of London
Stephen Wooding*****
Research Assistant Professor of Human Genetics, University of Utah
Ph.D., Anthropology, University of Utah
Author, “Evolution: A study in bad taste?” Current Biology (2005) 15: R805-R807.
Steven T. Wooldridge**
Technical Expert, Ford Research Laboratory
Ph.D., Mechanical Engineering, Stanford University
Stephen Wroe
Postdoctoral Fellow, University of Sydney
Ph.D., Paleontology, University of New South Wales
Stephen A. Wurst*****
Associate Professor of Psychology, State University of New York, Oswego
Ph.D., Experimental Psychology, New York University
Stephen L. Wust*
Hydrologist, Santa Fe County, New Mexico
Ph.D., Geology, University of Arizona
Stephen John Wylie*
Senior Research Officer, Western Australia State Agricultural Biotechnology Centre Centre (SABC) and Centre for Legumes in Mediterranean Agriculture, Murdoch University
Ph.D., Molecular Virology, Murdoch University
Steven M. Yannone******
Scientist, Life Science Division, Lawrence Berkeley National Laboratory
Ph.D., Biochemistry and Molecular Biology, University of California, Irvine
Stephen P. Yanoviak*
Postdoctoral Fellow, University of Texas Medical Branch
Ph.D., Zoology, University of Oklahoma
Steven Yantis
Professor of Psychological and Brain Sciences, Johns Hopkins University
Ph.D., Psychology, University of Michigan
Recipient of the Troland Research Award from the National Academy of Sciences
Steven J. Yellin****
Retired Professor of Physics in Residence, University of California at Santa Barbara
Ph.D., Physics, California Institute of Technology
Stephen Yeung****
Assistant Professor of Mathematics, University of San Francisco
Ph.D., Theoretical and Applied Mechanics, Cornell University
Stephen M. Yezerinac
Professor of Biology, Reed College
Ph.D., Biology, Carleton University
Stephen R. Yool****
Associate Professor of Geography, University of Arizona
Ph.D., Geography, University of California, Santa Barbara
2005 Distinguished Research Lecturer
Steven K. Yoshinaga******
Science Educator, Skybay Education
Ph.D., Molecular Biology, University of California, Los Angeles
Co-author, “T-Cell Co-Stimulation through B7RP-1 and ICOS,” Nature (1999) 402:827-832; designer of models for science (www.magdna.com)
Steven L. Young******
Associate Professor of Obstetrics and Gynecology, University of North Carolina at Chapel Hill
Ph.D., Biochemistry and Molecular Biology, University of Miami
Steven L. Youngentob**
Associate Professor of Neuroscience and Physiology, State University of New York Upstate Medical University
Ph.D., Physiology, State University of New York Upstate Medical Center
Stephan A. Zdancewic*
Assistant Professor of Computer and Information Science, University of Pennsylvania
Ph.D., Computer Science, Cornell University
Steven G. Zecker***
Associate Professor, Department of Communication Sciences and Disorders, Northwestern University
Ph.D., Psychology, Wayne State University
Stephan I. Zeeman
Professor of Biological Sciences, University of New England
Ph.D., Marine Sciences, University of South Carolina
Stephen L. Zegura
Professor of Anthropology, University of Arizona
Ph.D., Human Biology, University of Wisconsin, Madison
Stephen W. Ziser******
Professor of Biology, Austin Community College
Ph.D., Biology, University of New Mexico
* Added after the Project Steve 200 t-shirt was designed
** Added after the Project Steve 400 t-shirt was designed
*** Added after the Project Steve 440 t-shirt was designed
**** Added after the Project Steve 500 t-shirt was designed
***** Added after the Project Steve 600 t-shirt was designed
****** Added after the Project Steve 700 t-shirt was designed
******* Added after the Project Steve 1000 t-shirt was designed
† Deceased
Institutions and organizations are listed for purposes of identification only.
Institutions and organizations are not necessarily current. Updates are welcome.
originally created February 19, 2003
last updated May 3, 2012
Etiketler:
Steve Projesi, Evrimi kabul eden bilim adamları, evrimi kabul eden bilim insanları, Evrim Teorisini kabul eden Stevelerin listesi, Steve ile başlayan ve evrimi kabul eden bilim adamları, Stevelerin listesi
Thank you for sharring